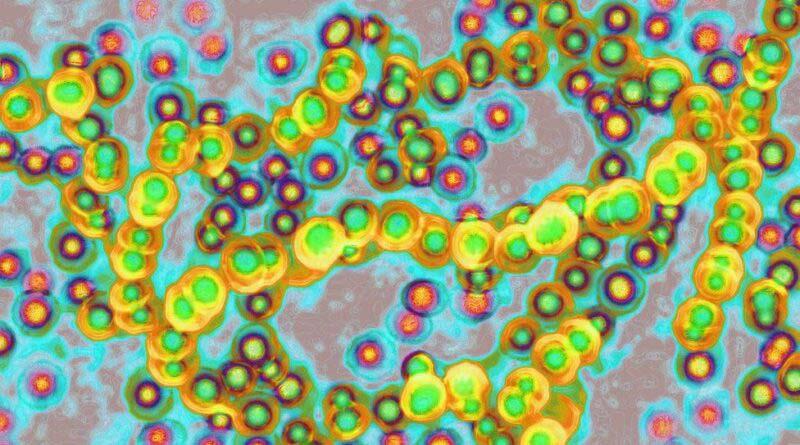

evsjv msjvc wi‡cvU©t c«avbgš¿x Fwl mybvK e‡j‡Qb ‡h wZwb ag©N‡Ui e¨vNvZ ‡_‡K gvbyl‡K i¶v Ki‡Z ÒbZyb K‡Vvi AvBbÓ wb‡q KvR Ki‡Qb| wZwb mvsm`‡`i e‡j‡Qb Òhw` BDwbqb ‡bZviv A‡hŠw³K n‡Z _v‡K, Z‡e we«wUk RbM‡Yi Rxeb I RxweKv i¶vi Rb¨ e¨e¯’v ‡bIqv Avgvi KZ©e¨Ó| wKš‘ ‡jevi ‡bZv m¨vi wKqvi ÷vigvi cwienb mwP‡ei gš—‡e¨i w`‡K Bw½Z K‡i‡Qb ‡h bZyb AvBb eZ©gvb wkí c`‡¶‡c mvnvh¨ Ki‡e bv|
GB kx‡Z hviv ag©NU Ki‡e Zv‡`i g‡a¨ bvm©, c¨viv‡gwWKm Ges ‡ij Kg©xiv i‡q‡Qb|

msm‡` GKwU wej DÌvcb Kiv n‡q‡Q hv ag©N‡Ui mgq cwienb ‡bUIqvK©¸wj‡Z b¨~bZg cwi‡levi ¯—i wbwðZ Ki‡e Z‡e GwU GLbI msm` m`m¨ Ges mnKg©x‡`i Øviv weZK© nqwb|
Gi Av‡M, U«v݇cvU© ‡m‡µUvwi gvK© nvc©vi Ggwc‡`i e‡jwQ‡jb ‡h bZyb AvBb fwel¨‡Z Òag©N‡Ui w`‡b hvÎx‡`i cwi‡levi DbœwZ Ki‡Z cv‡iÓ Z‡e GwU ÒAvR Avgiv ‡h wkí c`‡¶‡ci gy‡LvgywL nw”Q Zv‡Z mnvqZv Ki‡e bvÓ|
wZwb ‡hvM
Òhv‡Z hvÎx‡`i ag©N‡Ui w`b bv nqÓ|
WvDwbs w÷«U ag©NU ‡gvKv‡ejvq bZyb ‡Kv‡bv cwiKíbvi wek` weeiY ‡`‡e
bv Z‡e e‡j‡Q ‡h bZyb e¨e¯’v wb‡q KvR ÒPjgvbÓ|
¯^v¯’¨ mwPe g¨vU n¨vbKK AvMvgx wbe©vP‡b `vuov‡eb bv
evsjv msjvc wi‡cvU©t c«v³b ¯^v¯’¨ mwPe g¨vU n¨vbKK ‡NvlYv K‡i‡Qb ‡h wZwb AvMvgx mvaviY wbe©vP‡b Ggwc wnmv‡e `vuov‡eb bv| AvBwUwf wi‡qwjwU ‡kv AvB A¨vg G ‡mwjwe«wU-‡Z Ask ‡bIqvi ci Zv‡K KbRvi‡fwUf Ggwc wn‡m‡e eiLv¯— Kiv n‡qwQj| Fwl mybvK‡K GKwU wPwV‡Z, wgt n¨vbKK e‡jwQ‡jb ‡h wZwb Òm¤¢vebvi GKwU m¤ú~Y© bZyb RMZ Avwe®‹vi K‡i‡Qb hv wZwb A‡š^lY Ki‡Z AvM«nxÓ| wZwb ‡hvM K‡i‡Qb ‡h ivRbxwZwe`‡`i msm‡`i evB‡i ÒRbM‡Yi Kv‡Q ‡cŠuQv‡bvi bZyb DcvqÓ Lyu‡R ‡ei Ki‡Z n‡e| wZwb Zvi wPwVwU ‡kl K‡i‡Qb GB e‡j ‡h Òcvj©v‡g‡›U KvR Kiv Ges cwðg mv‡dv‡Ki RbM‡Yi c«wZwbwaZ¡ Kiv GKwU m¤§v‡biÓ| ÒAvwg Avgv‡`i ‡`‡ki fwel¨Z wb‡q weZ‡K© Avgvi
cªv³b `~i‡Z¡i wb‡`©wkKv j•Nb Kivi ci Zv‡K `vwqZ¡ ‡_‡K c`Z¨vM Ki‡Z eva¨ Kiv n‡qwQj|
f~wgKv cvjb Kie

¯—‡ii AvBb‡K mg_©b Kivi AvnŸvb Rvbvb| wZwb ‡jevi cvwUi« weiæ‡× ag©N‡Ui d‡j ¶wZM«¯— k«wgK I e¨emvwqK‡`i mg_©b w`‡Z A¯^xKvi Kivi Awf‡hvM K‡i‡Qb| wnmv‡e `vwqZ¡ cvjb K‡iwQ‡jb| 2021 mv‡ji Ry‡b, GKRb mnKg©x‡K Py¤^b K‡i mvgvwRK
KbRvi‡fwUf
evsjv msjvc wi‡cvU©t ivRvi w`‡K wWg Qy‡o gvivi c‡i mvaviY nvgjvi m‡›`‡n GKRb‡K ‡M«ßvi Kiv n‡q‡Q|
g½jevi ivRv Pvj©m jyUb kn‡ii ‡K‡›`« nvuUvi mgq Kw_Z NUbvwU N‡U| ‡eW‡dvW©kvqvi cywjk Rvwb‡q‡Q, 20 eQi eqmx GK e¨w³‡K AvUK Kiv n‡q‡Q Ges Zv‡K ‡ndvR‡Z ivLv n‡q‡Q|
Rbmvavi‡Yi m`m¨‡`i mv‡_ ‡`Lv Kivi Av‡M ivRv‡K Zvi wbivcËv Kg©xiv wfo ‡_‡K `~‡i mwi‡q w`‡qwQ‡jb|

me©‡kl NUbvwU BqK© md‡ii mgq ivRv Ges ivbx Kb‡mv‡Ui« w`‡K wWg Qyu‡o gvivi c‡i 23 eQi eqmx GK Qv·K ‡M«ßvi Kiv nq |
ivRKxq `¤úwZ m‡egvÎ 9 b‡f¤^i
BqK© wgwb÷v‡i c«qvZ ivbxi m¤§v‡b GKwU g~wZ© D‡b¥vPb Ki‡Z kn‡i G‡mwQ‡jb hLb PviwU wWg wb‡¶c Kiv n‡qwQj, hvi me¸wjB wgm n‡qwQj|
jyUb UvDb n‡j hviv ivRv Pvj©m‡K
Af¨_©bv Rvwb‡qwQ‡jb Zv‡`i A‡b‡KB Zv‡K Ò‡gwi wµmgvmÓ ï‡f”Qv Rvwb‡‡Qb, ‡KD ‡KD Zv‡K Dcnvi ‡`Iqvi Rb¨ Dcnvi wb‡q G‡m‡Qb|
ivRv Nvbv ‡mvmvBwU, iq¨vj we«wUk wjwRqb Ges jyUb UvDb dyUej GKv‡Wwgi cvkvcvwk ¸iæ bvbK ¸iæØvi gw›`i AvbyôvwbKfv‡e ‡Lvjv mn m¤cÖ`v‡qi ‡bZv‡`i mv‡_I
‡`Lv K‡ib| c‡i, ivRv WvU© (WvB‡i± Gqvi-‡ij U«vbwRU)-G P‡qwQ‡jb GKwU bZyb wegvbe›`i kvUj hv jyUb wegvbe›`i
cvK©I‡q ‡÷kb ‡_‡K Uvwg©bv‡j ågYKvix ‡jvK‡`i mshy³ Ki‡e|

_ vK‡e, mvnv‡h¨i Rb¨ ÷¨vÛevB‡Z ‡mbvevwnbxi mv‡_|
IqvKAvD‡Ui ïiæi mgq Ges ‰`N¨© BDwbqb Ges cwi‡lev¸wji g‡a¨ cwiewZ©Z nq, Z‡e me¸wj 12 N›Uv ‡_‡K 24N›Uvi g‡a¨
wnmv‡e AvuKvi m¤¢vebv wb‡q DwØMœ, GLbI ch©š— ‡c«vM«vg¸wj mwZ¨B wee«ZKi ev wek«x wKQy K‡iwb| c«vK-c«Pvi RvwZ Ges ‡ivcY M‡íi we‡ùviK mgm¨v¸wj DÌvcb K‡iwQj - Z‡e GLbI ch©š— Aš—Z, `¤úwZiv wb‡R‡`i‡K Kxfv‡e ‡`‡Lb ‡m m¤ú‡K© wmwiRwU AviI A‡bK ‡ewk c«Kvk K‡i‡Q| GUv Zv‡`i wb‡R‡`i Rb¨ GKwU ‡c«gcÎ. Zviv wb‡R‡`i‡K Aei“×, Kyms¯‹vi Ges ûgwKi m¤§yLxb, wgwWqvi mv‡_ hy‡× wb‡R‡`i Dc¯’vcb K‡i‡Qb| Ges ‡hgb GwU eÜy Ges we‡klÁ‡`i GKwU mg_©K ‡Kvivm mn evB‡ii w`‡K bq eis wfZ‡ii w`‡K ZvKv‡bv GKwU `…k¨| GKwU ivRKxq cwiev‡ii Rb¨ hv‡K ¯ú‡ki« evB‡i Ges mnvbyf~wZnxb ev eY©ev`x wnmv‡e AviI Lvivc wnmv‡e AvuKvi m¤¢vebv wb‡q DwØMœ, GLbI ch©š— ‡c«vM«vg¸wj mwZ¨B wee«ZKi ev wek«x wKQy K‡iwb| ivRv Pvj©m, K¨vwgjv `¨ KyBb Kb‡mvU©, wc«Ý DBwjqvg Ges K¨v_wib cUf~wg‡Z ‡i‡L ‡M‡Qb| GwU ¯úófv‡e ‡`Lvq ‡h wc«Ý n¨vwi Zvi gv, wc«‡Ým Wvqvbvi nviv‡bvi wel‡q KZUv gvbwmKfv‡e KvuPv i‡q ‡M‡Q| ‡gNv‡bi mv‡_ Zvi ‡ivg¨vÝ Zvi `yt‡Li AwfÁZvi mv‡_ RwoZ e‡j g‡b nq| wbDR jvB‡bi cwi‡c«w¶‡Z, me‡P‡q eo mgv‡jvPbv nj msev` ‡jLK‡`i weiæ‡×, ‡c«m‡K GKwU fyZy‡o Dcw¯’wZ wnmv‡e ‡`Lv nq, cvcvivw¾ ivRKxq `¤úwZ‡K Zvov K‡i Ges eY©ev`x Ace¨envi mn ‡mvk¨vj wgwWqv‡Z Zv‡`i Dci ‡c«m AvµgY c«mvwiZ nq| wc«Ý n¨vwi GB ai‡bi µgvMZ wgwWqv Abyc«‡ek Øviv ‡ewóZ GKwU Rxeb KvUv‡Z ¯Íä| hw` ivRcwiev‡ii mgv‡jvPbv
gymwjg wek¦ m¤^‡Ü g‡bi g‡a¨ cy‡l ivLv aviYv‡K cy‡ivcywi e`‡j w`‡”Q wek¦dyUej| we‡kl K‡i cwðwg `ywbqv ‡hfv‡e gymwjg R‡MK gbMov aviYv w`‡q `xN©w`b a‡i M‡o Zy‡j‡Q, ‡mB aviYv‡K M‡o ‡Zvjv I cwðwg g‡bvR‡MK m‡Rv‡i SvuwK‡q w`‡q GK bZyb evZ©v e‡q Avbj Gev‡ii wek¦Kvc dyUej|
Biv‡bi dyUej ‡L‡jvqvoiv ‡`wL‡q‡Q dyUej n‡Z cv‡i Avðh© GK c«wZev‡`i fvlv| Bivb c«kvm‡bi ag©xq ‡Mvovwgi weiæ‡× wnRvec«_v Zy‡j ‡`Iqvi mc‡¶ Biv‡bi ‡g‡q‡`i c«wZev‡`i Av‡›`vjb‡K mg_©b Rvbv‡jb Zviv| Bivwb RvZxq msMxZ hLb aŸwbZ nw”Qj gq`v‡bi g ‡_‡K Zviv `yB ‡VvuU Gu‡U ‡evev n‡q iB‡jb, gyL ‡gjv‡jb bv RvZxq msMx‡Zi ‡Kviv‡m| cviwmK ev Bivwb ‡L‡jvqvoiv KZ eo SyuwK wb‡jb Agb GK ‡evev hy‡×, Zv ‡`‡L wek¦ ¯—w¤¢Z—H ‡L‡jvqvoiv N‡i wdi‡j Kx kvw¯— Zv‡`i Rb¨ A‡c¶v Ki‡Q, Zviv fve‡jb bv eis A`g¨ dyUej Av‡eM‡K ey‡K ‡i‡L eyK mUvb I gv_v DbœZ ‡i‡L Zviv KvZv‡i KvZvi w`‡q `vuwo‡q iB‡jb; gymwjg ‡`k KvZviI wek¦dyUej Av‡qvR‡bi mg…× ZwiKvq I AvwfRv‡Z¨ mviv `ywbqv‡K ZvK jvwM‡q w`‡q‡Q|
dyUej Avm‡j c…w_exiB c«wZiƒc| gvbe Rxe‡bi GK wkwíZ c«wZ”Qvqv| dyUej wek¦gv‡bi e܇bi GK ‡k«ô Dcvq| e«vwR‡ji g‡Zv ‡`‡ki Kv‡Q, Zvi ‡jvK mvavi‡Yi Kv‡Q dyUejB ag©| ew¯—‡ZI e«vwR‡ji ‡Q‡j‡g‡qiv dyUej ‡L‡j| dyUej‡K GZ fv‡jvev‡m e«vwR‡ji gvbyl ‡h Zv‡`i GB fv‡jvevmvi _B wb‡Z wM‡q Kv‡bv dyUej fveyK j¶ K‡i‡Qb, dyUejB a‡gi« RvqMv wb‡q‡Q e«vwR‡ji ‡jvKRxe‡b| e«vwR‡ji K_v G‡j Av‡R©w›Ubvi K_ vI G‡m c‡o|
eiveiB Avwg wQjvg gviv‡`vbvi f³| AvRI Zvi c«wZ Avgvi fw³ GK ‡bvKZvI K‡gwb| AvRI Zvi ‡Uwjwfk‡b ‡`Lv ‡Ljvi ¯§…wZ g‡bi g‡a¨ Qwe n‡q Av‡Q| dyUej Zvi kixigq ‡Ljv K‡i wdiZ— ‡hb GKwU c…w_ex dyUe‡ji wek¦ ivRcy‡Îi me©v‡½ Py¤^b Ki‡Z Ki‡Z wb‡R‡KB ab¨ K‡i P‡j‡Q|

Ask ‡evSvq; nv‡Zi EaŸ©fv‡M ej jvM‡j ev evûi Ic‡ii fvM w`‡q ej ‡Lj‡jI dyUej ‡Ljvq ‡`vl nq bv|
gviv‡`vbv Kx K‡iwQ‡jb g‡b c‡o? nvZ w`‡q ‡V‡j ‡Mvj K‡iwQ‡jb; ‡idvwi gkvB ‡Zv bqB; RMrmsmvi KvKc¶x Ges `k©KgkvBiv ‡KDB ‡Ui cvbwb, dyUe‡ji ivRcyÎ gviv‡`vbv Zvi ‡mvbvi nvZ w`‡q c«wZc‡¶i ‡b‡U ‡MvjwKcv‡ii ‡Pv‡L ‡mvnvćbi Avwei Qwo‡q ‡Mvj K‡i‡Qb| wZwb Gfv‡e ‡Mvj Ki‡Z cv‡ib dyUej wek¦g ‡mw`b ‡f‡e DV‡ZB cv‡iwb| gviv‡`vbv Zvi nvZ w`‡q ‡V‡j ‡Mvj Kivi K_v wkïi g‡Zv wb‡RB e‡j ‡dj‡jb `ywbqvi m¤§y‡L|
GKUv wU‡gi w`‡K Zvi ‡`k ‡P‡q _v‡K| Avkv K‡i wek¦m¤§vb G‡b ‡`‡e Zvi wUg| gviv‡`vbvi ‡ejvq gviv‡`vbviB gyL cv‡b ‡P‡q _vKZ Av‡R©w›Ubv| wUg ev `j wQj `ye©j| wKš‘ gviv‡`vbvi GKvi kw³B wQj dyUe‡ji GK gnvwe¯§q| GKvB wZwb wek¦dyUe‡ji ‡Ljvi is e`‡j w`‡Z cvi‡Zb| Z_vwc dyUej wU‡giB HK¨e× ‡Ljv| ‡mB HK¨ i¶v Ki‡Z n‡j 11Rb ‡L‡jvqv‡oi g‡a¨ Aš—i½Zv PvB, c«‡Z¨K‡K gvb w`‡Z nq ‡Ljvi k…•Ljvi c«xwZc~Y© AvPi‡Y| ‡Ljvi gv‡V Ges me©Î| GKwU mr mgv‡Ri iƒc ‡`Lv hvq ‡Ljvi g‡a¨| Biv‡bi dyUej `j Bivwb mgv‡RiB Qwe Zy‡j aij we‡k¦i mvg‡b|
wnRvewe‡ivax bvix Av‡›`vjb mviv we‡k¦i bvix¯^vaxbZvi GK Abb¨ gvÎvq ‡cŠuQj| `‡ji AwabvqK Gnvmvb nvRmvwd ‡Mvcb iv‡Lbwb, ‡Kb Zv‡`i GB c«wZev`| Bivwb Pjw”PÎ bvixgyw³i K_v welq n‡q we‡k¦i mvg‡b G‡m‡Q `kK `yB-wZb Av‡MB| Gevi ‡Ljvq Gj ‡mB bvix gyw³i Rb¨ ‡gŠbc«wZev`| AvqvZyj vn ‡Lv‡gBwbi ‰¯^ivPviB Biv‡bi ‡kl K_v bq| a‡gi« ‡MvovwgB Biv‡bi Aš—ivZ¥v bq, g‡b ivL‡Z n‡e Bivb GKwU AvaywbK ‡`k, Zvi ‰eÁvwbK AM«MwZI eû`~i| G ev‡ii wek¦Kvc dyUej c«v‡P¨i Rb¨ GK be‡PZbvi nw`m e‡q Avbj Bivb| cvðvZ¨ ‡`k¸‡jv‡KI AvR ZvB gymwjg wek¦ m¤^‡Ü bZyb K‡i fve‡Z n‡e—AvdMvwb ag©‡gvn I Zvwjevwb AKvU¨ ‡Mvovwg‡K Pig
H NUbvi ci gviv‡`vbvi nvZLvwbi bvg n‡q ‡Mj ‡Mv‡ìb n¨vÛ| GKwU ‡`vl‡K Gfv‡e ¸Yvwš^Z Kiv Ges gviv‡`vbvi mZZv‡K AjsK…Z Kiv dyUe‡jiB GK KynKgq wKmmv, m‡›`n ‡bB| wKš‘ H NUbvi GKwU my›`i bvg w`‡Z cvwi Avgiv| Kx bvg ‡`e? ‡mvbvi nv‡Z ‡mvbvi ‡Mvj| wKš‘ gviv‡`vbvi mZZv dyUej g~j¨‡ev‡ai GK Avðh© g¨vwRK wi‡qwjRg ‡mwU| gviv‡`vbv ‡Zv bv ej‡jB cvi‡Zb ‡h, wZwb nvZ w`‡q ‡Mvj K‡i‡Qb| ‡Kbbv ‡KD ‡Zv Rv‡b bv, wZwb Kx K‡i ‡MvjUv Ki‡jb| wKš‘ wZwb ‡¯^”Qvq ej‡jb, dvDj| gviv‡`vbvi GB gnZ¡ we‡k¦i Kv‡Q GK `…óvš—| ‡m Kvi‡Y fveyKiv e‡j _v‡Kb, ‡Ljv ïay ‡Ljv bq| Avm‡j ‡LjvB Rxeb|
Bivb n‡jv ms¯‹…wZi ‡`k| Avh© mf¨Zvi cxV¯’vb| giwgqvev‡`i Zx_©‡¶Î| MR‡ji ‡`k, nvwd‡Ri mgvwaf~wg—iex›`«bv‡_i MxZvÄwji ‡c«iYv¯’j Bivb ev cvim¨| cviwmKiv iex›`«bv_‡K wb‡R‡`i Kwe g‡b K‡i| AwMœDcvm‡Ki ‡`k Bivb| BivbB c«_g nRiZ gyn¤§‡`i K_v Kvb ‡c‡Z ï‡bwQj| AvRI Biv‡bi c«avb Drme Av¸bDrme| evsjvfvlvi ‡c«iYv n‡jv dviwm| cvi‡m¨i fvlv evsjvfvlv‡K c«Kvk¶g K‡i Zy‡jwQj cvwk© ev dviwm fvlv| d‡j Biv‡bi c«wZ evOvwji GKwU AvwZ¥K Uvb i‡q‡Q| dviwm fvlvwU ms¯‹…‡Zi m‡nv`iv| fviZ-Bivb `~i bq| g‡b ivL‡Z n‡e Bivb Av¸b R¡vjv‡Z cv‡i| Biv‡bi ‡L‡jvqvo‡`i Rb¨B
AvNvZ nvbj| Bivb-AvdMvb ‡hb wb‡R‡K e`jv‡Z ‡k‡L, ‡mB dyUej evZ©vB ‡i‡L w`‡q ‡Mj KvZvi wek¦Kvc|
‡Ljv ‡kl n‡e| wKš‘ ‡eMevb GK ms¯‹…wZ Pj‡ZB _vK‡e wek¦ Ry‡o| gyw³ ¯^vaxbZv gyw³| mwi‡q `vI bvixi gy‡Li Ici ‡Rvi K‡i Pvwc‡q ‡`Iqv AveiY| bvixi ‡PvL `ywU ¯úó n‡q DVyK, Zvi ‡mŠ›`h© Pvu‡`i gvaex c~wY©gvi g‡Zv cy‡iv AvKvk fwi‡q ZyjyK| ‡Kbbv bvixB Avm‡j GB c…w_exi A‡a©K AvKvk| c…w_ exUv mwZ¨B dyUe‡ji g‡Zv ‡Mvj| Aš—Z f~‡Mv‡ji ‡Mv‡ei g‡Zv ‡Mvj, ‡mwU Ny‡iB P‡j‡Q|
I fvl¨Kvi
evsjv msjvc wi‡cvU©t ‡÷«‡ÞvK°vm G AvµvšÍ ¯‹y‡ji QvÎiv e¨vK‡Uwiqvi msµg‡Y bqwU wkï gviv hvIqvi c‡i c«wZ‡ivag~jK A¨vw›Uev‡qvwU‡Ki wm×vš— wb‡q‡Q KZ©…c¶ | ¯‹yj gš¿x wbK wMe e‡j‡Qb A¨vw›Uev‡qvwU‡Ki e¨envi ÒGKwU weKíÓ Ges ‡mvgevi nvDm Ad jW©‡m welqwU DÌvwcZ n‡qwQj| me©‡kl g…Z¨yi g‡a¨ GKwU cvuP eQi eqmx ‡g‡q e‡j g‡b Kiv nq ‡h ‡ejdv‡÷i GKwU c«v_wgK we`¨vj‡q c‡o| KZ©…c¶ ¯‹y‡ji mv‡_ wbweofv‡e KvR Ki‡Q| hy³iv‡R¨i evwK Ask Ry‡o, ‡m‡Þ¤^i ‡_‡K ‡÷«c G e¨vK‡Uwiqv msµg‡Yi RwUjZvi Kvi‡Y AvU wkï gviv ‡M‡Q| A‡±ve‡i ¯‹vi‡jU R¡‡ii c«v`yf©v‡ei (hv ‡÷c G Øviv m…ó nq) m¤úwK©Z BD‡K wb‡`©wkKv Avc‡WU Kiv n‡q‡Q, G‡Z ejv n‡q‡Q A¨vw›Uev‡qvwUK e¨envi Kiv ‡h‡Z cv‡i ‡÷«cG-Gi bZyb ‡Km eÜ Ki‡Z mvnvh¨ Kivi Rb¨ ¯‹y‡ji g‡Zv ‡mwUs‡m Z‡e ¯’vbxq c«v`yf©ve-wbqš¿Y `‡ji mv‡_ GKwU wm×vš— ‡bIqv DwPZ Ó msµg‡Yi wfwˇZ |Ó we«÷j BDwbfvwm©wUi ‡cwWqvwU«‡·i Aa¨vcK A¨vWvg wdb wewewm wbDR‡K e‡jb, wPwKrmvi Rb¨ evi GLb Kwg‡q

Avbv n‡Z cv‡i| Òc«wgZ wb‡`©wkKv nj ‡h Avcwb A¨vw›Uev‡qvwUK wb‡q hvIqvi Av‡M ¯‹y‡ji g‡Zv GKwU c«wZôv‡b `ywU msµg‡Yi Rb¨ A‡c¶v Kiæb… Z‡e msµg‡Yi msL¨v Ges GB gyû‡Z©

KbRvi‡fwUf
evsjv msjvc wi‡cvU©t ‡Uvwi wcqvi wg‡kj ‡gv‡b jW©m ‡_‡K Abycw¯’wZi QywU wb‡”Qb ÒZvi weiæ‡× Ab¨vqfv‡e ‡h Awf‡hvM¸wj Kiv n‡q‡Q Zvi bvg cwi®‹vi Ki‡ZÓ| Gi A_© nj wZwb nvD‡mi ‰eV‡K ‡hvM ‡`‡eb bv, ‡Kv‡bv Kvh©avivq ‡fvU ‡`‡eb bv ev ‡Kv‡bv fvZv `vwe Ki‡Z cvi‡eb bv| e¨vi‡bm ‡gv‡b wcwcB ‡gW‡c«vi mv‡_ hy³ n‡q‡Qb| Zvi AvBbRxexiv Av‡M e‡jwQ‡jb ‡h ÒwcwcB ‡gW‡c«v‡Z Zvi ‡Kvb f~wgKv ev KvR ‡bBÓ|
Zvi gyLcvÎ e‡j‡Qb, Abycw¯’wZi QywU ÒZvr¶wYKfv‡e Kvh©KiÓ Ges GwU e¨vi‡bm ‡gv‡bi wm×všÍ|
Gi A_© nj Zv‡K Zvi Avw_©K ¯^v_© wbeÜb Ki‡Z n‡e bv, hw`I Zvi Abycw¯’wZi QywUi Aby‡iva c«Z¨vL¨vb Kiv ‡h‡Z cv‡i| e¨vi‡bm ‡gv‡b Gwc«j ‡_‡K jW©‡m ‡fvU ‡`bwb Ges 2020 mv‡ji gvP© ‡_‡K weZ‡K© K_v e‡jbwb| 2020 mv‡ji ‡g ‡_‡K Ry‡bi g‡a¨, wcwcB ‡gW‡c«v‡K gv¯‹ Ges ‡gwW‡Kj MvDb mieiv‡ni Rb¨ 203 wgwjqb cvDÛ g~‡j¨i `ywU miKvwi Pyw³ ‡`Iqv n‡qwQj| A¯^vfvweKfv‡e, ‡Kv¤úvwbi eqm gvÎ K‡qK mßvn wQj hLb GwU c«_g Pyw³‡Z ¯^v¶i K‡iwQj|
¯úóZB we`¨gvb D‡Ø‡Mi Kvi‡Y, ‡mB wb‡`©wkKv¸wj fvjfv‡e mvgÄm¨ Kiv ‡h‡Z cv‡i Ges Avgiv n‡Z cvwi AviI we¯—…Z A¨vw›Uev‡qvwUK e¨envi ‡`Lyb|Ó wgt wMe wRwe wbDR‡K e‡j‡Qb: ÒjW© gvinvg MZKvj nvDm Ad
jW©‡m e‡j‡Qb ‡h BD‡K ‡nj_ A¨vÛ wmwKDwiwU G‡RwÝ Ae¯’vbwU ch©‡e¶Y Ki‡Q Ges ‡h mg¯— ¯‹y‡j msµgY i‡q‡Q ‡mLv‡b GB ai‡Yi mgm¨v¸wj we‡ePbv Ki‡Q| ÒGwU GKwU Pjgvb cwiw¯’wZ,
BD‡KGBPGmG ‡mB ¯‹yj¸wji mv‡_ Lye Nwbôfv‡e RwoZ Ges Zviv cieZ©x‡Z AviI civgk© c«`vb Ki‡e ÒZ‡e GwU ‡mB wbw`©ó ¯‹yj¸wji Rb¨ GKwU weKí n‡Z cv‡i ‡hLv‡b msµgY i‡q‡Q|Ó
Ki‡Z A¶g KviY ÒwelqwU GKwU ‡dŠR`vwi Z`‡š—i Ask wnmv‡e cywjk ev Ab¨ ms¯’vi Øviv Z`šÍvaxbÓ| GB eQ‡ii ïiæ‡Z b¨vkbvj µvBg G‡RwÝ ‡Kv¤úvwbi mv‡_ hy³ m¤úw˸wj AbymÜvb K‡iwQj| Z‡_¨i ¯^vaxbZv AvB‡bi Aax‡b c«KvwkZ B‡gj¸wj ‡`Lvq ‡h e¨vi‡bm ‡gvb gnvgvix PjvKvjxb GKwU miKvix gš¿xi Kv‡Q ms¯’vwU‡K D‡jL K‡i‡Qb| MZ gv‡m, ‡jevi ‡WcywU wjWvi A¨v‡Äjv ‡ibvi miKvi‡K wcwcB ‡gW‡c«v‡K Pyw³ c«`v‡b Òh_vh_ cwik«‡gi m¤ú~Y© e¨_©ZvÓ Ges Ò¯^v‡_i« Øb&ØÓ e‡j Awfhy³ K‡iwQ‡jb| wZwb dvum nIqv bw_¸wji Dci wfwË K‡i MvwW©qv‡bi GKwU Z`‡š—i c«wZwµqv Rvbvw”Q‡jb ‡h e¨vi‡bm ‡gvb ‡Kv¤úvwb ‡_‡K Avw_©Kfv‡e jvfevb n‡q‡Qb e‡j Awf‡hvM Kiv n‡q‡Q| wZwb mvsm`‡`i e‡jwQ‡jb ‡h GwU Ò‡Kv¤úvwb‡K ‡`Iqv A_© ‡_‡K K‡qK wgwjqb cvDÛÓ ÒRwoZ e¨w³‡`i mv‡_ mshy³ Ad‡kvi A¨vKvD‡›U ‡kl n‡q‡QÓ e‡j g‡b n‡”Q| e¨vi‡bm ‡gv‡b me©‡kl Awf‡hv‡Mi wel‡q gš—e¨ Kivi Aby‡iv‡ai Reve ‡`bwb|
evsjv msjvc wi‡cvU©t ‡gU Awdm mZK© K‡i‡Q ‡h GB mßv‡n hy³iv‡R¨ Zxe« VvÛv AvenvIqv ïiæ n‡Z P‡j‡Q, ‡hLv‡b ivZvivwZ ZvcgvÎv K‡g gvBbvm 6 wWM«x ‡mjwmqvm n‡e| DËi ¯‹Uj¨v‡Û Zylvicv‡Zi m¤¢vebv i‡q‡Q, hw`I ZvcgvÎv h‡_ó Kg n‡e |
ZylvicvZ Ges eidI c«Z¨vwkZ| we`¨y‡Zi `vg evo‡jI ‡jv‡K‡`i Zv‡`i wnwUs e¨envi Kivi Rb¨ Ges we‡kl K‡i SyuwKc~Y© ‡jvK‡`i mÜvb Kivi Rb¨ Aby‡iva Kiv n‡”Q|
BD‡K ‡nj_ wmwKDwiwU G‡RwÝ (BD‡KGBPGmG) Ges ‡gU Awdm Bsj¨v‡Ûi ‡ewkifvM As‡k eyaevi 6 Uv ‡_‡K 9Uv ‡mvgevi 12 wW‡m¤^‡ii g‡a¨ GKwU ¯—‡ii VvÛv AvenvIqvi mZK©Zv Rvwi K‡i‡Q D”P-SyuwKc~Y© ‡Mvôx¸wj‡K i¶v Kivi Rb¨ c`‡¶c wb‡Z ¯—iwU mvgvwRK Ges ¯^v¯’¨‡mev


cwi‡lev¸wj‡KI mZK© K‡i‡Q|
eyaevi DËi ¯‹Uj¨v‡Û Zylvicv‡Zi Rb¨ GKwU njy` AvenvIqv mZK©Zv Rvwi Kiv
n‡q‡Q|
wewewm I‡q`v‡ii mvBgb wKs e‡j‡Qb ‡h, g½jevi ivZ ‡_‡K Ges mßv‡ni evwK mgq, AvK©wUK ‡_‡K Dˇii GKwU
evZvm AviI kxZj K‡i Zyj‡e, ‡`ke¨vcx ZvcgvÎv 1 wWM«x ‡mjwmqvm ‡_‡K 4 wWM«x ‡mjwmqvm ch©šÍ_vK‡e| wgt wKs e‡jb, ÒAvgiv
mßv‡ni ‡kl bvMv` ZvcgvÎv wngv‡¼i wb‡P ‡b‡g hvIqvi mv‡_ mv‡_ ivZvivwZ e¨vcK ZylvicvZ ‡`L‡Z hvw”Q|Ó
Òhy³iv‡R¨i ‡ewkifvM As‡k
Avgiv hv ‡`L‡Z cve Zv nj ‡iv` Avgv‡`i A‡b‡KiB ‡mB VvÛv, Lv¯Ív, ‡iv‡`jv mKvj n‡e|Ó
g‡a¨ GB eQi 5% ‡eZb e…w× Ges c‡ii eQi 4% AšÍf©y³ i‡q‡Q Ges 31 mvj ch©š— mvaviY ‡M«W Ges
Kg©x‡`i
‡KvbI eva¨Zvg~jK Ac«‡qvRbxqZv ‡bB| wKš‘ ‡mvgevi, BDwbqb GKwU B‡jKU«wbK MY‡fv‡U Zvi m`m¨‡`i ‡bUIvK© ‡ij ‡_‡K GKwU bZyb Advi w`‡q‡Q, hv GK mßv‡ni g‡a¨ eÜ n‡q hv‡e| Gi mvaviY m¤úv`K c«¯ÍvewU‡K Ò`wi`«Ó wnmv‡e eY©bv Kivi c‡i Gi m`m¨‡`i AwZwi³ wkí c`‡¶c‡K mg_©b Kivi Rb¨ AvnŸvb Rvbv‡bv n‡”Q| BDwbqb ‡ij ‡Wwjfvwi Mªyc (RDG) ‡_‡K Av‡iKwU c«¯Íve c«Z¨vL¨vb Kivi ciciB GwU Av‡m, hv ‡U«b Acv‡iUi‡`i c«wZwbwaZ¡ K‡i|
‡MvôxwU Kv‡Ri Abykxj‡b ‡ek K‡qKwU cwieZ©‡bi c«¯Íve K‡iwQj hv e‡jwQj ‡h GB eQi 5% Kg©x‡`i ‡eZb e… w×i Rb¨ A_©vqb Ki‡Z mvnvh¨ Ki‡e, Avw_©K eQ‡ii ïiæ‡Z e¨vK‡W‡UW, cieZ©x eQi AviI 4% n‡e
evsjv msjvc wi‡cvU©t ‡÷«c G ‡iv‡M AvµvšÍ nIqvi ci AviI GKRb c«v_wgK we`¨vj‡qi QvÎ gviv ‡M‡Q, Gi d‡j hy³iv‡R¨ G ‡iv‡M g…‡Zi msL¨v `vuoov‡jv 8|
IqvUvijywfj, n¨v¤úkvqv‡ii ‡gvij¨vÛm c«vBgvixi wkï Ges Kg©xiv GB Uª¨v‡RwWi c‡i ÔweaŸ¯Í e‡j Rvbv ‡M‡Q| ‡mvgevi c«avb wk¶K A¨vwjmb mvB‡iW-cj GB Lei wbwðZ K‡i‡Qb|
wZwb e‡jwQ‡jb: ÔLye `ytLRbKfv‡e, Avgiv mv¤cÖwZK w`b¸wj‡Z Avgv‡`i ¯‹y‡j cov GKwU wkïi g…Z¨yi wel‡q Rvb‡Z ‡c‡iwQ, ‡hwU GKwU AvµgYvZ¥K Mªyc G ‡÷«‡Þv‡KvKvj (AvBwRGGm) msµg‡Y AvµvšÍ n‡qwQj|
ÔAvgiv Avgv‡`i GK Zi“Y wk¶v_©xi ¶wZ ‡`‡L G‡Kev‡i weaŸ¯Í Ges GB AZ¨š— `ytLRbK mg‡q mšÍv‡bi cwiev‡ii c«wZ Avgv‡`i
AvšÍwiK mg‡e`bv RvbvB| ÔAvgiv cwiev‡ii ‡MvcbxqZv‡K m¤§vb Ki‡Z PvB| cwievi, Avgv‡`i QvÎ Ges Kg©xiv hv‡Z mg_©b cvq Zv wbwðZ Ki‡Z
Avgiv Rb¯^v¯’¨ KZ©…c‡¶i mv‡_ Nwbôfv‡e KvR KiwQ|Õ wg‡mm ‡miW-cj ‡hvM K‡i‡Qb ‡h ¯‹yjwU Mªyc G ‡÷«‡Þv‡KvKvj (AvBwRGGm) msµg‡Yi
j¶Y¸wji wel‡q ‡jvK‡`i mZK© Kivi Rb¨ KvR Ki‡Q ÔmZK©Zv wnmv‡eÕ|
`¨ wbD‡Ri mv‡_ K_v ejvi mgq, wZwb e‡jwQ‡jb ‡h evev-
gv, ZË¡veavqK Ges e…nËi ¯‹yj m¤cÖ`vq‡K civgk© ‡`Iqv n‡qwQj ‡h hw` GKwU wkï G ‡iv‡M Avµvš— nq Z‡e Kx Kiv DwPZ| BD‡K ‡nj_ wmwKDwiwU G‡RwÝ
evsjv msjvc wi‡cvU©t jÛ‡b 12 eQi eqmx ‡Q‡j ‡÷«c G e¨vK‡Uwiqvq gviv ‡M‡Q , GUv c«_g ‡Kvb gva¨wgK we`¨vj‡qi QvÎ ‡h ¶wZKi ‡÷«c G e¨vK‡Uwiqvq gviv ‡M‡Q, wi‡cvU© ej‡Q|
‡Q‡jwU jyBkv‡gi ‡Kvj‡di ¯‹y‡j Bqvi 8 Gi QvÎ wQj e‡j aviYv Kiv n‡”Q|
BD‡K ‡nj_ wmwKDwiwU G‡RwÝ (BD‡KGBPGmG) e‡jwQ‡jb ‡h GwU c…_K ‡¶‡Î gš—e¨ Kiv hvqbv, Z‡e ‡Q‡jwU‡K GKwU c«Li ivMwe ‡L‡jvqvo e‡j g‡b Kiv nq Ges hy³iv‡R¨ msµg‡Y Avµvš— nIqvi c‡i Kgc‡¶ Qq wkï gviv hvIqvi ci G NUbv N‡U | Mªyc G ‡÷«c e¨vK‡Uwiqv ¯‹vi‡jU R¡i Ges ‡÷«c Mjv mn wewfbœ msµg‡Yi
KviY n‡Z cv‡i|
hw`I ‡ewkifvM msµgY Zyjbvg~jKfv‡e nvjKv nq, GwU KLbI KLbI AvµgYvZ¥K Mªyc


Kivi K_v e‡j‡Qb KviY Zvi ‡g‡q ‡÷«c G-‡Z AvµvšÍ nIqvi c‡i GKwU ‡fw›U‡jU‡i Rxeb‡K AvuK‡o a‡i Av‡Qb|
K¨vwgjv ‡ivR evb©m c«v_wgKfv‡e Zvi ey‡K e¨_vi wel‡q Zvi evevgv‡qi Kv‡Q Awf‡hvM Kivi c‡i AwffveKiv Ab¨‡`i msµg‡Yi j¶Y m¤ú‡K© mZK© Ki‡Qb|
e‡j‡Q ‡h GB mßv‡ni ‡kl ch©š— ‡Km Ges g…Z¨yi RvZxq cwimsL¨vb c«Kvk Kiv n‡e bv| Mªyc G ‡÷«‡ÞvK°vm nj GK ai‡Yi e¨vK‡Uwiqv‡K ‡`Iqv bvg hv KLbI KLbI Mjv ev Z¡‡K cvIqv hvq|
GwU mvaviYZ Mjv e¨_v Ges Z¡‡Ki msµg‡Yi g‡Zv nvjKv Amy¯’Zvi KviY nq Ges ‡ewkifvM ‡jvKB GwU ‡Kv‡bv j¶Y QvovB enb K‡i|
hw`I K`vwPr, GB e¨vK‡Uwiqv AvµgYvZ¥K Mªyc G ‡÷«‡ÞvK°vj ‡ivM bvgK ¸i“Zi Ges c«vYNvZx Amy¯’Zvi KviY n‡Z cv‡i|
hw`I GLbI A¯^vfvweK, BD‡K ‡nj_ wmwKDwiwU G‡RwÝ (BD‡KGmGBPG) Gi cwimsL¨vb Abymv‡i, AvµgYvZ¥K Mªyc G ‡÷«‡ci ‡¶‡Î eZ©gv‡b GK ‡_‡K Pvi eQi eqmx wkï‡`i g‡a¨ ¯^vfvwe‡Ki ‡P‡q Pvi¸Y ‡ewk|
4 eQi eqmx MZ ïµevi eÜy‡`i mv‡_ bvPwQj wKš‘ wjfvicy‡ji A¨vìvi ‡n wPj‡W«b nvmcvZv‡j wb‡q hvIqvi c‡i GLb ‡fw›U‡jU‡i ÒZvi Rxe‡bi Rb¨ jovBÓ Ki‡Q, Zvi evev e‡j‡Qb|
evsjv msjvc wi‡cvU©t KbRvi‡fwUf ‡Pqvig¨vb bvw`g RvnvDB e‡j‡Qb, wµmgv‡mi mgq miKvwi-Lv‡Zi ag©N‡Ui gva¨‡g BDwbqb¸wji c‡¶ ÒRbM‡Yi Rxeb e¨vnZ KivÓ AbywPZ|
wZwb e‡jwQ‡jb IqvKAvDU GwM‡q ‡M‡j A¨v¤^y‡jÝ Pvjv‡bv Ges mxgvš— myiw¶Z Kivi Rb¨ mvgwiK evwnbx‡Z Lmov Kivi cwiKíbv i‡q‡Q|
wgt RvnvDB wewewm‡K e‡j‡Qb ivwkqvi ‡c«wm‡W›U f&jvw`wgi cywZb ag©NU Ò‡`L‡Z PvbÓ, Z‡e BDwbqb¸wj Gi mgv‡jvPbv K‡i‡Q|
‡eZb I kZ© wb‡q we‡iv‡a wewfbœ wk‡íi nvRvi nvRvi k«wgK PjwZ gv‡m ag©NU Ki‡Z P‡j‡Qb|
wKQy BDwbqb e‡j‡Q ‡eZb RxebhvÎvi e¨‡qi mv‡_ wgwjZ nIqv DwPZ, hv 40 eQ‡ii g‡a¨ `ªyZZg nv‡i e…w× cv‡”Q, g~jZ Lv`¨ I GbvwRi« `vg e…w×i d‡j GwU n‡q‡Q|
GbGBPGm, ‡ijI‡q Ges iq¨vj ‡gjGi Kg©x‡`i c«wZwbwaZ¡Kvix BDwbqb¸wj Øviv me‡P‡q nvB-‡c«vdvBj ag©N‡Ui WvK ‡`Iqv n‡q‡Q|
Bsj¨vÛ, I‡qjm Ges DËi Avqvij¨v‡Ûi bvmi«v GB gv‡m `yB w`b a‡i ag©NU Ki‡e, hv GbGBPG‡mi
BwZnv‡m Zv‡`i me‡P‡q eo IqvKAvDU n‡Z P‡j‡Q|
Ab¨Î, wW‡m¤^i Ges Rvbyqvwi‡Z PviwU 48-NÈvi mgq Ry‡o ‡ij ag©NU AbywôZ n‡e, hv hvÎxiv eow`‡bi åg‡Y gvivZ¥K e¨vNv‡Zi m¤§yLxb n‡e| wewewmi iweevi jiv Ky‡qbmevM© ‡c«vM«v‡g GKwU mv¶vZ&Kv‡i wgt RvnvDB‡K
wRÁvmv Kiv n‡qwQj ‡h miKvi ag©NU ‡kl Ki‡Z Kx Ki‡Q| gš¿x e‡jb, BD‡µ‡b ‡c«wm‡W›U cywZ‡bi hy× hv R¡vjvwb LiP evwo‡q w`‡q‡Q `vg e…w× Ges ‡eZb e…w×i Pv‡ci c«avb PvjK KviY GwU|
miKvi evievi BDwbqb Ges wb‡qvMKZ©v‡`i gxgvsmv Kivi Rb¨ Ges
ag©NU eÜ Kivi Rb¨ Aby‡iva K‡i‡Q, e‡j‡Q ‡h GwU gy`«vùxwZ Kfvi Kivi Rb¨ ‡eZb e…w×i mvg_¨© ivL‡Z cv‡i bv|

÷«vB‡Ki c«fve ‡gvKv‡ejvq RbmvaviY‡K mvnvh¨ Kivi Rb¨ miKvi Kx Ki‡e Rvb‡Z PvB‡j wgt RvnvDB e‡jb, ÒAvgiv Kw›Ub‡RwÝ c¨vb Pvjy KiwQÓ|
GB cwiKíbv¸wji g‡a¨ i‡q‡Q c«vq 2000 mvgwiK Kg©x Ges ‡emvgwiK Kg©Pvix‡`i c«wk¶‡Yi gva¨‡g wegvbe›`i Ges e›`‡i eW©vi ‡dvm© mn miKvwi cwim‡i mnvqZv Kivi Rb¨ |
miKvi A¨v¤^y‡jÝ W«vBwfs Ges AwMœwbe©vcY mn f~wgKv¸wj‡Z mvgwiK Kg©x‡`i m¤¢ve¨ ‡gvZv‡qb Kivi cwiKíbv Ki‡Q|
wgt RvnvDB jiv Kyh‡qbmevM©‡K e‡j‡Qb, ÒAvgvi `…wó‡Z, BDwbqb¸wji c‡¶ wµmgv‡m gvby‡li Rxeb I RxweKv‡K mwZ¨B ¶wZM«¯’ Kiv Ges e¨vnZ Kiv Ab¨vq|Ó
ÒZv‡`i GB wel‡q cybwe©‡ePbv Kiv Ges c«wZdwjZ Kiv DwPZ KviY cywZb wVK GUvB ‡`L‡Z Pvb| Avmyb wef³ bv n‡q, Avmyb GKwÎZ nB|Ó
we‡ivax `j¸‡jv ej‡Q, k«wgK‡`i b¨vh¨ ‡eZb e…w× Ki‡Z A¯^xKvi K‡i miKvi ag©N‡Ui Rb¨ `vqx n‡”Q|
wjev‡ij ‡W‡gvKª¨vU‡`i K¨vwe‡bU Awd‡mi gyLcvÎ wµw÷b RvwW©b e‡j‡Qb, Òbvm©‡`i ag©N‡Ui Rb¨ f&jvw`wgi cywZb‡K `vqx Kivi civgk© ‡`Iqv nvm¨Ki Ges AcgvbRbK|Ó
mš— vb‡`i Rb¨ GKwU we‡kl wµmgvm evZ©v ‡iKW© K‡i‡Qb|
wWDK Ad mv‡m· `vZe¨ ms¯’v, ¯‹wUÕm wjUj ‡mvjRvim Øviv Av‡qvwRZ GKwU evwl©K wµmgvm cvwU©‡Z ‡hvM`vbKvix wkï‡`i Rb¨ ü`qM«vnx wfwWI evZ©v cvwV‡qwQ‡jb|

`vZe¨ ms¯’vi j¶¨ Zv‡`i mg_©b Kiv hviv we«wUk mvgwiK evwnbx‡Z Kgi«Z wcZvgvZvi g…Z¨yi AwfÁZv AR©b K‡i‡Qb|
¯úvBWvig¨v‡bi
c«wZ eQi GKwU wfbœ ¯’v‡b AbywôZ nq Ges ¯‹wUi m`m¨‡`i Zv‡`i g‡Zv GKB
cwiw¯’wZ‡Z Ab¨‡`i mv‡_ ‡`Lv Kivi my‡hvM ‡`q, Zv‡`i wew”QbœZvi Abyf~wZ Kgv‡Z mvnvh¨ K‡i Ges Zv‡`i g‡b Kwi‡q ‡`q ‡h Zviv Zv‡`i `yt‡L GKv bq| wc«Ý n¨vwi Gi Av‡M 2019 mv‡j Zv‡`i wµmgvm cvwU©‡Z ¯‹wUi m`m¨‡`i Rb¨ GKwU wfwWI ‡iKW©
K‡iwQ‡jb| wWDK ‡mB mg‡q dv`vi wµmgv‡mi ‡cvkvK c‡iwQ‡jb|
‡Rwg ¯§j, 8, GKRb AskM«nYKvix whwb 2016 mv‡j Zvi evev, K‡c©vivj wµ‡÷vdvi ¯§j‡K nvwi‡qwQ‡jb, e‡jwQ‡jb: ÒGwU ‡ek PgrKvi ‡h wc«Ý n¨vwi ¯‹wUÕm‡K mg_©b K‡ib| GwU ‡Kej GKwU ‡QvU M«v‡gi ‡jvK bq| wZwb Ggb GKRb whwb mviv we‡k¦i gvbyl Rv‡bb Ges wZwb Avgv‡`i Rb¨ GKwU we‡kl evZ©v ‡iKW© Kivi Rb¨ mgq wb‡q‡Qb, hvi A_© A‡bK|Ó ‡eb IÕ‡Wv‡bj, whwb gvÎ bq mßv‡ni eq‡m Zvui evev M¨vwi IÕ‡Wv‡bj gviv wM‡qwQ‡jb, e‡jwQ‡jb: Òwc«Ý n¨vwi GB
evsjv msjvc wi‡cvU©t GB eQi ‡K›U KvDw›U KvDw݇j Avj‡ewbqv ‡_‡K Avmv m½xnxb wkï Awfevmx‡`i c«vq 20% wb‡LvuR n‡q‡Q, wewewm Lyu‡R ‡c‡q‡Q|
¯’vbxq KZ©…c¶ 31 A‡±vei ch©š— 197 Avj‡ewbqvb wkï‡K wb‡qwQj wKš‘ Zv‡`i g‡a¨ 39 Rb wb‡LvuR n‡q‡Q|
BKc¨vU BD‡K, hv wkï‡`i ‡kvlY ‡_‡K i¶v Kivi Rb¨ c«PviYv Pvjvq, e‡j‡Q ‡h cwimsL¨vb¸wj LyeB D‡ØMRbK|
KvDwÝj e‡j‡Q ‡h Zviv Aiw¶Z wkï‡`i myi¶vi Rb¨ ‡nvg Awdm Ges cywj‡ki mv‡_ Nwbôfv‡e KvR K‡i‡Q|
Z‡_¨i ¯^vaxbZvi Aby‡iv‡ai gva¨‡g wewewm GB cwimsL¨vb ‡c‡q‡Q|
KvDwÝj e‡j‡Q ‡h ‡nvg Awd‡mi ‡K›U Bb‡UK BDwb‡U c«wµqvK…Z 197 Avj‡ewbqvb wkï 1 Rvbyqvwi ‡_‡K 31 A‡±ve‡ii g‡a¨ Zv‡`i h‡Zœ G‡m‡Q| GwU ‡hvM K‡i‡Q ‡h, 7 b‡f¤^i ch©šÍ 39 Rb‡K wb‡LvuR wnmv‡e ‡iKW© Kiv
n‡qwQj| GB wkï‡`i g‡a¨ wKQy 18 eQi eqmx n‡e| GB eQi G ch©š— Avj‡ewbqv ‡_‡K 12,000 GiI ‡ewk Awfevmx ‡bŠKvqK‡i hy³iv‡R¨ ‡cŠu‡Q‡Q 2021 mv‡ji Zyjbvq c«vq 4,000% e…w× ‡c‡q‡Q|
Bwg‡M«kb gš¿x ievU© ‡RbwiK GB mgm¨vwU Zy‡j a‡i‡Qb , wZwb e‡j‡Qb wKQy ‡QvU ‡bŠKvq, 80% ‡ev‡W© wQ‡jb Avj‡ewbqv ‡_‡K|
GKc¨vU BD‡K-Gi bxwZ, A¨vW‡fv‡Kwm Ges M‡elYvi c«avb

jiv Wyivb e‡j‡Qb wb‡LvuR wkï‡`i msL¨v ÒmwZ¨B ‡ewkÓ | wZwb e‡jwQ‡jb: ÒAvgiv mwZ¨B DwØMœ ‡h Zviv ‡kvl‡Yi SyuwK‡Z i‡q‡Q ev Kvh©Kifv‡e cvPvi n‡q‡Q| ÒZviv wbg©vY ev Mvwo ‡avqvi g‡Zv
wewfbœ wk‡í k«g ‡kvl‡Yi gy‡LvgywL n‡Z cv‡i; gv`K weZi‡Y ev MvuRvi Lvgv‡i Zv‡`i Acivag~jKfv‡e ‡kvlY Kiv n‡Z cv‡i, ev Zv‡`i ‡hŠb ‡kvlY Kiv n‡Z cv‡i|Ó
GKwU wee…wZ‡Z, ‡K›U KvDw›U KvDwÝj e‡j‡Q ‡h Zv‡`i cwi‡lev¸wj‡Z D‡jL Kiv AweevwnZ Avj‡ewbqvb wkï‡`i msL¨vq ÒD‡jL‡hvM¨ e…w×Ó ‡`‡L‡Q|
G‡Z ejv n‡q‡Q: Òhw`I mg¯— mnMvgx Avk«q-c«v_©x wkï ‡kvl‡Yi Rb¨ SyuwKc~Y©… M‡elYv Ges AwfÁZv c«gvY K‡i ‡h wKQy ‡jvK we‡klfv‡e `ye©j Ges ¯’vbxq KZ©…c‡¶i hZœ ‡_‡K Lye `ª„Z nvwi‡q ‡h‡Z cv‡i|
Ò‡K›U KvDw›U KvDwÝj b¨vkbvj ‡idv‡ij ‡gKvwbRg mn DfqB c«wZwôZ myi¶v ‡c«v‡UvKj e¨envi K‡i‡Q Ges GB wkï‡`i hZUv m¤¢e SyuwK Kgv‡Z eû-G‡RwÝ ‡KŠkj¸wj ïi K‡i‡Q
ÒKvDwÝj Zvi h‡Zœ Avk«qc«v_©x mKj mnvq-m¤^jnxb wkï‡`i myi¶vqmwµq f~wgKv cvjb K‡i P‡j‡Q|Ó
Qq wkï gviv hvIqvi c‡i ¯^v¯’¨ Awdmviiv wcZvgvZv‡`i ‡÷«c G-Gi j¶Y¸wji w`‡K bRi ‡`Iqvi Rb¨ Aby‡iva Ki‡Qb| ‡÷«c G msµgY mvaviYZ nvjKv nq, hvi d‡j Mjv e¨_v ‡_‡K ¯‹vi‡jU R¡i ch©š— Amy¯’Zv ‡`Lv ‡`q, Z‡e GwU AviI ¸iæZi AvµgYvZ¥K Mªyc G ‡÷«c (AvBwRGGm) msµg‡Y cwiYZ n‡Z cv‡i| we‡klÁiv ej‡Qb, G eQi ¯^vfvwe‡Ki ‡P‡q ‡ewk ‡÷«c G-Gi NUbv N‡U‡Q| c«‡dmi weU Kv¤úg¨vb e‡jb, AwffveK‡`i wPwš—Z n‡j Zv‡`i wPwKrmv mnvqZv ‡bIqv DwPZ| ¯^v¯’¨ Kg©KZ©viv ïµevi wbwðZ K‡i‡Qb ‡h ‡m‡Þ¤^i ‡_‡K QqwU wkï AvBwRGGm-Gi mv‡_ gviv ‡M‡Q hvi g‡a¨ cvuPwU Bsj¨v‡Ûi 10 eQ‡ii Kg eqmx Ges I‡qj‡mi GKwU ‡g‡q i‡q‡Q| ¯‹Uj¨vÛ ev DËi Avqvij¨v‡Û ‡Kv‡bv g…Z¨yi Lei wbwðZ Kiv nqwb| BD‡K ‡nj_ wmwKDwiwU G‡RwÝ e‡j‡Q ‡h ‡klevi ‡÷«c G msµg‡Yi GKwU wbweo mgq wQj 2017-18 mv‡j, hLb mgvb mg‡qi g‡a¨
KviY
cv‡i Ges Zv‡`i g‡a¨ wKQy AviI ¸i“Zi| GKwU nj ¯‹vi‡jU R¡i, hv ‡ewkifvMB ‡QvU ev”Pv‡`i c«fvweZ K‡i | ¯‹vi‡jU R¡i wK? GwU GKwU j¶Yxq ‡ivM, hvi A_© ¯^v¯’¨ ‡ckv`vi‡`i Aek¨B ¯’vbxq ¯^v¯’¨ myi¶v `j‡K m‡›`nRbK ‡¶‡Î AewnZ Ki‡Z n‡e| GwU hv‡Z Zv‡`i `ªyZ wPwKZ&mv Kiv hvq Ges m¤¢ve¨ c«v`yf©ve wbqš¿‡Y Avbv hvq| GwU GKwU dymKywo Ges d¬y-Gi g‡Zv DcmM© m…wó K‡i, hvi g‡a¨ i‡q‡Q ZvcgvÎv, Mjv e¨_v Ges dy‡j hvIqv
Nv‡oi M«wš’| Mvo Z¡‡K dymKywo¸wj `…k¨Z mbv³ Kiv AviI KwVb n‡Z cv‡i Z‡e GKwU
AvBwRGGm
evsjv msjvc wi‡cvU©t PZy_© wkïwU ‡÷«c G e¨vK‡Uwiqv msµg‡Y gviv ‡M‡Q | BD‡K ‡nj_ wmwKDwiwU G‡RwÝ (BD‡KGBPGmG) wbwðZ K‡i‡Q jÛ‡bi ‡÷«c G fvBiv‡m Z…Zxq wkïi g…Z¨y n‡q‡Q |
me©‡kl g…Z¨y nj cwðg jÛ‡bi BwjsGi ‡m›U Rbm ¯‹y‡j cov GK wkïi| I‡qj‡mi GKwU wkï GB ‡iv‡M gviv ‡M‡Q e‡j ‡NvlYv Kivi c‡i GwU G‡m‡Q Ges MZ gv‡m mv‡i‡Z GKwU c«v_wgK we`¨vj‡q msµg‡Y Ab¨ GKwU wkï gviv ‡M‡Q|
Ab¨w`‡K evwKsnvgkvqv‡ii GKRb Pvi eQi eqmx ‡Q‡j 14 b‡f¤^i gviv ‡M‡Q, GwU AvR c«KvwkZ n‡q‡Q |
Mªyc G ‡÷«‡Þv‡KvKvj (AvBwRGGm) ‡ivMwU ¯‹vi‡jU wdfv‡ii KviY n‡Z cv‡i|
‡÷«c‡Uv‡KvKvj d¨vwiÄvBwUm ev ‡÷«c ‡_«vU nj Ggb GK ‡ivM hv ÒMªyc G ‡÷«c‡Uv‡KvKvmÓ bvgK e¨vK‡Uwiqvi Kvi‡Y nq| ‡÷«c ‡_«vU Mjv Ges Ubwmj Gi ¶wZ K‡i| Ubwmj nj gyL Gi wcQb w`‡K Mjvi
`yÕwU M«wš’ | ‡÷«c ‡_«vU ¯^ih‡š¿iI (evMhš¿) ¶wZ Ki‡Z cv‡i| BD‡KGBPGmG e‡j‡Q ‡h GwU
¯‹y‡j Rb¯^v¯’¨ civgk© Ges mnvqZv c«`v‡bi Rb¨ Bwjs KvDw݇ji mv‡_ KvR Ki‡Q|
Mªyc G ‡÷«‡ÞvK°vj (wRGGm) msµgY ‡÷«‡ÞvK°vm cvB‡R‡bm e¨vK‡Uwiqvi ‡÷«‡bi Kvi‡Y nq|
e¨vK‡Uwiqv nvZ ev Mjvq `xN©¶Y ‡eu‡P _vK‡Z cv‡i hv‡Z nvuwP, Py¤^b Ges Z¡‡Ki ms¯ú‡ki« gva¨‡g gvby‡li g‡a¨ mn‡R Qwo‡q co‡Z cv‡i|
‡ewkifvM msµg‡Yi Kvi‡Y nvjKv Amy¯’Zv nq ‡hgb Ò‡÷«c ‡_«vUÓ, ¯‹vi‡jU wdfvi ev Z¡‡Ki msµgY|
e¨vK‡Uwiqv Lye KgB my¯’ gvbyl‡K msµvwgZ K‡i Z‡e hw` GwU kix‡i c«‡ek K‡i, ¸iæZi Ges GgbwK c«vYNvZx Ae¯’vi m…wó K‡i Z‡e GwU AvµgYvZ¥K wRGGm (AvBwRGGm) bv‡g cwiwPZ|
BD‡KGBPGmG jÛ‡bi ¯^v¯’¨ myi¶v civgk©K Wvt Bqvwg PvD e‡j‡Qb: Ò‡m›U RbÕm c«vBgvwi ¯‹y‡j GKwU wkïi g…Z¨yi Lei ï‡b Avgiv AZ¨šÍ `ytwLZ, Ges Avgv‡`i wPš—v Zv‡`i cwievi, eÜyevÜe Ges ¯‹yj m¤cÖ`v‡qi mv‡_|
ÒBwjs KvDwÝj Rb¯^v¯’¨ `‡ji mv‡_ KvR K‡i, Avgiv AviI msµgY c«wZ‡iv‡a mnvqZv Kivi Rb¨ ¯‹yj m¤cÖ`vq‡K mZK©Zvg~jK civgk© w`‡qwQ Ges Avgiv cwiw¯’wZ wbweofv‡e ch©‡e¶Y KiwQ |Ó

evsjv msjvc wi‡cvU©t ¯^v¯’¨ Awdmviiv ej‡Qb ‡÷«c G bvgK msµgY m¤ú‡K© AwffveK‡`i m‡PZb nIqv DwPZ, hy³iv‡R¨ GB msµg‡Y 6 wkïi g…Z¨yi ci Awdmviiv D‡ØM c«Kvk K‡i‡Qb| ‡h‡nZy ‡KvwfW wewawb‡la wkw_j n‡q‡Q, ZvB GB ai‡bi msµgY Qwo‡q covi AviI my‡hvM i‡q‡Q| mv¤cÖwZK mßvn¸wj‡Z ‡Km evo‡Q| hw`I ‡ewkifvM gvbyl Lye ‡ewk Amy¯’ nq bv, Z‡e AZ¨š— msµvgK e¨vK‡Uwiqv hv msµgY NUvq Zv ¸iæZi Amy¯’Zv Ges RwUjZv m…wó Ki‡Z cv‡i|
‡÷«c G wK? GwU GKwU e¨vK‡Uwiqv hv KLbI KLbI Mjv ev Z¡‡K cvIqv hvq| A‡b‡K bv ‡R‡bI ¶wZKviKfv‡e GwU enb K‡i, Z‡e Zviv GwU Ab¨‡`i g‡a¨ Qwo‡q w`‡Z cv‡i | wKfv‡e Avcwb GwU ‡c‡Z cv‡ib? ‡jvK‡`i g‡a¨ Nwbô ‡hvMv‡hv‡Mi gva¨‡g Ges Kvwk Ges nvuwP ‡_‡K n‡Z cv‡i| c«v`yf©ve KLbI KLbI ¯‹yj

m¤¢ve¨
c«v`yf©ve wbqš¿‡Y Avbv hvq| GwU GKwU dymKywo Ges d¬y-Gi g‡Zv DcmM© m…wó K‡i, hvi g‡a¨ i‡q‡Q ZvcgvÎv, Mjv e¨_v Ges dy‡j hvIqv Nv‡oi M«wš’| MvX Z¡‡K dymKywo¸wj `…k¨Z mbv³ Kiv AviI KwVb n‡Z cv‡i Z‡e GKwU m¨vÛ‡ccv‡ii Abyf~wZ n‡e|
¯‹vi‡jU R¡i Av‡Q Ggb Kv‡ivi n‡Z cv‡i hv‡K Wv³viiv ÷«‡ewi wRnŸv e‡j _v‡Kb KviY Gi ‡Pnviv ‡`L‡Z A‡bKUv ÷«‡ewii g‡Zv|
‡÷«c G GKwU wec¾bK? Lye KgB, ‡÷«c G AvµgYvZ¥K Mªyc G ‡÷«‡Þv‡KvKvj msµgY ev AvBwRGGm bvgK wKQy m…wó Ki‡Z cv‡i| GwU gvivZ¥K n‡Z cv‡i| AvµgYvZ¥K ‡ivM N‡U hLb e¨vK‡Uwiqv Avcbvi kix‡ii ‡ivM c«wZ‡iva ¶gZv AwZµg K‡i| GwU NU‡Z cv‡i hLb Avcwb BwZg‡a¨B Amy¯’ ev wPwKrmv wb‡”Qb, ‡hgb wKQy K¨vÝvi ‡_ivwc, hv Avcbvi BwgDb wm‡÷g‡K c«fvweZ K‡i|
AvµgYvZ¥K ‡iv‡Mi mZK©Zv j¶Y¸wji g‡a¨ i‡q‡Q:
mvRy Avn‡g`t Kvix wKs,A¯‹vi L¨vZ Òwe«wUk Kvix A¨vIqvW©Ó-Gi dvDÛvi giûg Gbvg Avjx GgweB ‡K Mfxi k«×v I fv‡jvevmvq ¯§i‡Yi gva¨‡g m¤úbœ n‡jv AvVv‡ivZg we«wUk Kvix A¨vIqvW©mÕi| 28 b‡f¤^i ‡mvgevi ‡m›U«vj jÛ‡bi evUviwm Gfy‡jkb cv‡K© wbwg©Z Kvix A¯‹v‡ii mywekvj n‡j ‡PvuL avavu‡bv Av‡qvR‡b AbywôZ we«wUk Kvix A¨vIqvW© g‡K eive‡ii g‡ZvB ewY©j K‡i Zy‡jb wek¦L¨vZ ‡mwj‡e«wUiv| Kvix BÛvw÷i ‡c«w÷wRqvm G Av‡qvR‡b ‡hgb _v‡K BwZnvm-HwZn¨ Ges ms¯‹…wZi ewY©j cwiPq| ‡Zgwb ‰kwíK we«wUk Kvix A¨vIqvW©‡K Ab¨ me Av‡qvRb ‡_‡K e¨wZµgx K‡i ‡Zvjvi gva¨‡g Abb¨ GK D”PZvq wb‡q wM‡qwQ‡jb B‡f›U gv÷vi L¨vZ Gbvg Avjx GgweB|
`xN© ‡`o hy‡Mi c_Pjvq Gbvg Avjx GgweB c~e© cyiæ‡li k«gI Nv‡g M‡o DVv we«‡U‡bi A_©bxwZ‡Z mivmwi wewjqb cvD‡Ûi Ae`vb ivLv Kvix G BÛvw÷«‡K ïay e¨emv bq GKwU HwZn¨evnx wkí wn‡m‡e m¤§v‡bi Avm‡b c«wZwôZ Ki‡Z Aweivg KvR K‡i‡Qb Zvui Rxe‡bi 45 eQi|
PjwZ eQ‡ii RyjvB gv‡m giYe¨vwa K¨vÝv‡i Avµvš— n‡q AvKw¯§K g… Z¨yeiY K‡ib Kvix wk‡íi wKse`wš—| ZvB Ab¨ mg‡qi ‡P‡q Gev‡ii we«wUk Kvix A¨vIqvW© wQj Mfxi ‡kvK I k«×vq gyn¨gvb| me wKQy mg‡qi MwZ‡Z Pj‡jI Gbvg Avjx wenxb G Av‡qvRbwU wQj ‡kv‡K Av”Qbœ| Dcw¯’Z Aw_wZ‡`i gy‡L wQj Mfxi ‡kvK I k«×v c«Kv‡ki cvkvcvwk Kvix wk‡íi weKv‡k Zvui Abb¨ KvR ¸‡jv‡K evuwP‡q ivLvi kc_|
GB Abyôv‡b be c«wZwôZ Gbvg Avjx
dvD‡Ûk‡bi Rb¨ AbywóZ AKk‡b Dcw¯’Z gvbyl `yB nvZ Ly‡j GwM‡q Av‡mb. 10 wU AvB‡Ug ‡_‡K c«vq ‡KvwU UvKvi (c«vq 80 nvRvi cvDÛ) dvÛ msM«n Kiv nq Zvr¶wYK fv‡e. ïaygvÎ mv‡eK c«avbgš¿x DBb÷b PvwP©j Gi mvBb ‡`qv GKUv wPwV AKk‡b wewµ Kiv nq 50 nvRvi cvDÛ. GB UvKv we‡jZ I evsjv‡`‡k K¨vÝvi msµvš— P¨vwiwU‡Z LiP Kiv n‡e e‡j Rvbv hvq.


we«wUk Kvix A¨vIqvW© Gi c«‡hvRK Gbvg Avjx GgweB Kb¨v Rvw÷b Avjxi mvwe©K ZZ¡veav‡b I ‡mwj‡e«wU ‡c«‡R›Uvi I K‡gwWqvb, Awf‡bZv I ‡jLK wnD ‡Wwb‡mi Dc¯’vcbvq Abyôv‡b D‡Øvabx e³e¨ iv‡Lb we«wUk Kvix A¨vIqvW©Õi wW‡i±i giûg Gbvg Avjx GgweB cyÎ ‡Rwd« Avjx| D‡Øvabx e³‡e¨ ‡kv‡K AvcyZ ‡Rwd« Avjx evevi Rb¨ ‡`vAv Kvgbv K‡i e‡jb,
Rxe‡bi 45 eQi Avgvi evev Gbvg Avjx GgweB Kvix BÛvw÷«i DbœwZ I G wk‡íi mv‡_ RwoZ‡`i Rb¨ KvR K‡i ‡M‡Qb| wZwb ej‡Zb ‡i÷y‡i›U e¨emv mvaviY ‡Kv‡bv e¨emv bq, GwU GKwU wkí Ges Gi AvaywbKvq‡b Zvui KvR wQj MZvbyMwZK avivi evwn‡i| evev ¯^cœ ‡`L‡Zb, bZyb c«Rb¥‡K Kvix BÛvw÷R Gi mv‡_ m¤ú…³ Kivi Ges G Rb¨ hy‡Mi mv‡_ Zvj wgwj‡q Gi AvaywbKvq‡b wZwb we«wUk miKv‡ii m‡e©v”P gn‡j `vwe Rvbv‡Zb|
we«wUk Kvix A¨vIqvW© wW‡i±i ‡Rwd« Avjx eZ©gvb Kvix wk‡íi msK‡Ui K_v D‡jL K‡i e‡jb, GK w`‡K ÷vd msK‡Ui Kvi‡Y hLb wewjqb cvD‡Ûi Ki c«`vbKvix wkíwU ayu‡K ayu‡K wbt‡kl nw”Q‡jv ZLbI Ny‡i `vuov‡Z ‡Póv wQj wk‡íi mv‡_ mswkó‡`i wKš‘ wbZ¨ c«‡qvRbxq c‡Y¨i g~j¨ c«vq 45 fvM e…w×i Kvi‡Y wV‡K _vKv GLb hy‡×i g‡Zv n‡q hv‡”Q| ‡Rwd« e‡jb,
‡cuqv‡Ri `vg GLb AvKvkPy¤^x| ‡Zj Qvov ‡hLv‡b Lvevi ‰Zixi m¤¢e bq ‡mLv‡b ‡Z‡ji `vg GLb aiv ‡Qvqvi evwn‡i P‡j ‡M‡Q| ‡Rwd« cwiw¯’wZ‡K msKUgq D‡jL K‡i e‡jb, Avgvi evev mevB‡K wb‡q HK¨e× KvR Kivi ¯^cœ ‡`L‡Zb| Avmyb Avgiv G msKU DËi‡Y GK mv‡_ KvR Kwi|
Abyôv‡b wfwWI evZ©vq, c«avbgš¿x, Fwl mybvK e‡jb,ÓAvgvi Rxe‡b Kv‡Ri me‡P‡q eo c«wk¶Y ‡¶Î wQj Kvix nvD‡R KvR Kiv| G KvR Ki‡Z wM‡q Avwg ‡`‡LwQ GKwU ‡ióy‡i‡›Ui g¨v‡bRvi, ‡kd, I‡qUvi, ‡Wwjfvwi W«vBfvi KZUv cwik«g K‡ib| c«avbgš¿x nIqvi wel‡q ‡mB AwfÁZv Avgv‡K ‡h c«wk¶Y w`‡q‡Q ‡mUv n‡jv, gvby‡li mv‡_ b¨vh¨ AvPiY Kivi ¸iæZ¡| c«avbgš¿x e‡jb, we«wUk Gwkqvb wk‡íi g‡a¨ me‡P‡q AvBKwbK wkí n‡jv Kvix wkí| wZwb giûg Gbvg Avjx GgweB I Zvui Abe`¨ ‰Zix we«‡U‡bi ÔKvwi A¯‹viÕ‡K mg_©b Ki‡Z ‡c‡i Avbw›`Z D‡j L K‡i e‡jb, Gbvg Avjx GgweB Avcwb Avgv‡`i Rb¨ Ges Avgv‡`i fwel¨r ‡Rbv‡ik‡bi Rb¨ hv wKQy K‡i‡Qb Ges ‡i‡L ‡M‡Qb G Rb¨ Avwg Avcbv‡K ab¨ev` Rvbv‡Z PvB|Ó hy³iv‡R¨i Kvix wk‡íi ‡c«w÷wRqvm Abyôvb wnmv‡e wek¦e¨vcx ¯^xK…Z G A¨vIqvW©‡K c«v³b c«avbgš¿x ‡WwfW K¨v‡gib ÔKvwi A¯‹viÕ D‡jL K‡i e‡j wQ‡jb, we«‡U‡bi gvby‡li nvDR ‡nvì Lvevi wP‡Kb wU°v gmjv| we«wU«k bvMwiKiv G Lvevi Qvov mßv‡ni GKwU w`bI wPš—v K‡i bv| G wkí‡K D”P gh©v`vq wb‡q ‡h‡Z KvR Ki‡Qb Gbvg Avjx GgweB Ges ÒKvix A¯‹viÓ we«wUk Kvix A¨vIqvW©|
eive‡ii g‡ZvB we«wUk Kvwi A¨vIqvW©-Gi AvVv‡ivZg Abyôv‡b ivRbxwZ, ‡Ljvayjv, ‡kvweR Ges L¨vZbvgv e¨w³‡`i g‡a¨ Dcw¯’Z wQ‡jb wUwf e¨w³Z¡ wµm U¨viv›U, bvw`qv G‡m· (‡m‡je ‡Mv ‡WwUs), Wt iÄ wms, gvwj©b wM«wd_m, ‡nBwj ¯úvK©m (w`m gwb©s), W¨vwb‡qj g¨vmb, mvqiv Lvb, Awf‡bZv ‡Rgm Km‡gv, wbbv Iqvw`qv, c«v³b Bsj¨vÛ dyUejvi ‡WwfW mxg¨vb, AvBm ‡¯‹Uvi d«vw¼ ‡cvëwb, mv‡eK Bsj¨vÛ wµ‡KUvi wdj Uvd‡bj, wi‡qwjwU wUwf ZviKv dvivn mvËvi, wk¶vbwek c«wZ‡hvMx wbK kvIqvwis Ges Ggwc wµm ‡M«wjs| A¨vIqvW© Abyôv‡bi c«avb c…ô‡cvlK wQj kxl©¯’vbxq AbjvBb dyW AW©vwis Ges ‡Wwjfvwi c¨vUdg© Rv÷ BU|
2022 Gi we«wUk Kvix A¨vIqvW© hviv ‡c‡jb: ¯‹Uj¨vÛ Gi ‡k«ó ‡i÷y‡i›U A¨vIqvW© AR©b K‡i Mvm‡MvÕi Ô¯^‡`k ‡i÷y‡i›UÕ, b_©-B÷ BD‡Ki ‡k«ô ‡i÷y‡i‡›Ui A¨vIqvW© AR©b K‡i wbDK¨vmj-Gi LvB LvB BwÛqvb ‡i÷y‡i›U, b_©I‡q÷ BD‡Ki ‡k«ô ‡i÷y‡i›U Gi A¨vIqvW© AR©b K‡i wjfvicyj-Gi ‡gvMwj w÷«U dyW, B÷ wgWj¨vÛmÕi ‡k«ó ‡i÷y‡i›U A¨vIqvW© AR©b K‡i bwUsnvg-Gi ÔK¨vjKvUv K¬veÕ ‡i÷y‡i›U, I‡q÷ wgWj¨vÛm Gi ‡k«ó A¨vIqvW© AR©b K‡i evwg©snv‡gi Ôjvmvb ‡i÷y‡i›UÕ, I‡j‡mi ‡k«ô ‡i÷y‡i›U A¨vIqvW© AR©b K‡i KvwW©d-Gi Ôcv‡c©j cccvWgÕ, mvD_ B÷ Gi ‡miv ‡i÷y‡i›U A¨vIqvW© AR©b K‡i ‡K‡›Ui I‡q÷vin¨v‡gi Ôk¨v¤úvb A¨vU w¯úwbs ûBjÕ‡i÷y‡i›U,
evsjv msjvc wi‡cvU©t Bsj¨v‡Û 10 eQ‡ii Kg eqmx cvuPRb mn ‡÷«c G fvBiv‡m 8 wkï gviv ‡M‡Q hy³iv‡R¨i ¯^v¯’¨ myi¶v ms¯’v Rvwb‡q‡Q|
I‡qj‡mi GK ‡g‡qI gviv ‡M‡Q| ¯‹Uj¨vÛ ev DËi Avqvij¨v‡Û ‡Kv‡bv g… Z¨yi Lei wbwðZ Kiv nqwb| ‡÷«c G msµgY mvaviYZ nvjKv nqwKš‘ Aí msL¨K ‡¶‡Î ‡ivMx ¸iæZi Amy¯’ n‡q co‡Z cv‡i| BD‡KGBPGmG civgk© w`‡q‡Q Zv‡`i mšÍv‡bi DcmM© wb‡q DwØMœ AwffveK‡`i wPwKrm‡Ki civgk© ‡bIqv DwPZ|

hw`I GLbI A¯^vfvweK, GB eQi AvµgYvZ¥K Mªyc G ‡÷«‡ci ‡¶‡Î e… w× ‡c‡q‡Q,
‡h‡Z cv‡i D`vniY¯^iƒc dymdym Ges i³ c«ev‡n AvµgYvZ¥K Mªyc G ‡÷«c bv‡g cwiwPZ
‡W¯‹ wi‡cvU©t Biv‡bi A¨vUwb© ‡Rbv‡ij GKwU ag©xq m‡¤§j‡b e‡j‡Qb, Bmjvwg bxwZ- ‰bwZKZv wb‡q Lei`vwi Kivi Rb¨ ‰Zwi ‡m‡`‡ki we‡kl cywjk evwnbx‡K ‡f‡O ‡`Iqv n‡q‡Q|

wnRve bv civi Rb¨ GB evwnbxi nv‡Z AvUK gvnmv Avwgwb bv‡g 22 eQ‡ii GK Zi“Yxi g…Z¨yi ci Biv‡b MZ AvovB gvm a‡i Pjv mwnsm we‡¶v‡fi ‡c«¶vc‡U ‡gvnv¤§` Rvdi ‡gvbZv‡Rwii KvQ ‡_‡K GB ‡NvlYv G‡jv|
Z‡e Biv‡bi wbivcËv evwnbx ev miKv‡ii AviI DuPy gnj ‡_‡K Ggb wm×v‡š—i K_v GLbI wbwðZ Kiv nqwb|
bvix‡`i Bmjvwg ‡W«m ‡KvW ev ‡cvkvK cwiavb mn Bmjvwg wewfbœ bxwZ‰bwZKZvi c«‡qvM wbwðZ KivB wQj givwjwU ev ‰bwZKZv welqK GB cywjk evwnbxi Ab¨Zg c«avb KvR|
Z‡e wewewm dvwm© fvlv wefv‡Mi msev``vZv wmfvk Avi`vjvb ej‡Qb, givwjwU cywjk ‡f‡O ‡`Iqvi A_© GB bq ‡h Biv‡b wnRve civi eva¨evaKZv iwnZ Kiv n‡”Q| wZwb e‡jb, miKvi GB wm×vš— hw` mwZ¨B wb‡q _v‡K Zvn‡j Zv Zv Pjgvb we‡¶vf c«kwgZ Ki‡e ‡m m¤¢vebv LyeB Kg| KviY, we‡¶vfKvixiv bZyb K‡i wZb w`‡bi ag©NU ‡W‡K‡Q|

‡W¯‹ wi‡cvU©t XvKvq ivR‰bwZK i¨vwji ‡c«w¶‡Z ågY mZK©Zv w`‡q‡Q e…wUk miKvi| Zviv e‡j‡Q, ivR‰bwZK i¨vwj mwnsm msNv‡Z iƒc wb‡Z cv‡i| AvBb c«‡qvMKvix ms¯’v¸‡jvi m‡½ GB mwnsmZv NU‡Z cv‡i| wbR¯^ I‡qemvB‡U ‡cv÷ Kiv mZK©Zvq ejv n‡q‡Q, 10B wW‡m¤^i XvKvq ivR‰bwZK i¨vwj nIqvi K_ v| G‡Z cwienb, ‡hvMv‡hvM ‡bUIqvK© Ges PjvP‡j weN&b NU‡Z cv‡i| 10B wW‡m¤^i‡K ‡K›`« K‡i K‡qKw`‡b AvBb c«‡qvMKvix‡`i Dcw¯’wZ e…w× ‡c‡Z cv‡i| Gi ‡c«w¶‡Z e… wUk bvMwiK‡`i mZK© K‡i IB wee…wZ‡Z me iKg eo mgv‡ek, we‡kl K‡i ivR‰bwZK mgv‡ek Gwo‡q Pj‡Z civgk© ‡`qv n‡q‡Q| g½jevi Avc‡WU Kiv ågY mZK©Zvq h_vixwZ Ab¨vb¨ wel‡qI ‡Rvi ‡`qv n‡q‡Q|
ejv n‡q‡Q, Avcwb evsjv‡`k md‡ii Av‡M ÔGw›U« wi‡Kvqvi‡g›UmÕ ‡mKkb cix¶v K‡i ‡`L‡eb| ‡KvwfW-19 Gi ‡c«w¶‡Z G wbqgbxwZ mZK©Zv QvovB e`‡j ‡djv n‡Z cv‡i| G wel‡q me©‡kl civgk©
XvKvq
AbymiY Ki‡Z ejv n‡q‡Q| G‡Z AviI ejv n‡q‡Q, c«wZ eQi c«vq ‡`o jvL e…wUk bvMwiK evsjv‡`k mdi K‡ib| Z‡e Zviv Sv‡gjvgy³ _v‡Kb| el©vKv‡j GB mdi n‡Z cv‡i wec¾bK| wee…wZ‡Z AviI ejv nq, GLbI evsjv‡`‡k mš¿vmx‡`i nvgjvi eo Avk¼v Av‡Q| GB ûgwK mviv‡`‡kB we`¨gvb| XvKv, Lyjbv, PÆM«vg
Ges wm‡j‡U cywjk Ges wbivcËv i¶vKvix‡`i Uv‡M©U K‡i Gi Av‡M nvgjv n‡q‡Q| fwel¨‡Z ag©xq mgv‡ek, ivR‰bwZK mgv‡ek, RbvKxY© GjvKv, cywjk ev wbivcËv i¶vKvix‡`i Dcw¯’wZi ¯’vb Ges we‡`wkiv ‡hLv‡b mg‡eZ nb e‡j cwiwPZ- ‡mLv‡b GB SyuwK Av‡Q| ZvB Gme ¯’vb‡K Gwo‡q Pj‡Z civgk© ‡`qv
n‡q‡Q e…wUk‡`i| mZK©Zvq AviI wKQy Bm¨y Zy‡j aiv n‡q‡Q, hv Gi Av‡M ‡`qv mZK©ZvqI Av‡Q| gvwK©b `~Zvevm evsjv‡`‡ki c«avb `ywU eo ivR‰bwZK `j 10B wW‡m¤^i XvKvi i¨vwji ‡NvlYv w`‡q‡Q| kvwš—c~Y©fv‡e nIqvi K_v _ vK‡jI GB we‡¶vf msNvZgq n‡q DV‡Z cv‡i| e…w× ‡c‡Z
cv‡i mwnsmZv| G K_v D‡j L K‡i evsjv‡`‡k Ae¯’vbiZ wb‡R‡`i bvMwiK‡`i mZK© K‡i‡Q XvKv¯’ gvwK©b `~Zvevm| wbR¯^ I‡qemvB‡U G wel‡q GKwU wee…wZ w`‡q‡Q Zviv| ejv n‡q‡Q, 2024 mv‡ji Av‡M A_ev IB eQ‡ii Rvbyqvwi‡Z evsjv‡`‡k cieZ©x RvZxq wbe©vPb nIqvi K_v i‡q‡Q| Gi ‡c«w¶‡Z ivR‰bwZK
`j¸‡jv mfvmgv‡ek I Ab¨ wbe©vPb‡K›`«xK Kg©KvÛ GiB g‡a¨ ïiæ K‡i‡Q| wbe©vPb hZ Nwb‡q Avm‡e, ZZB Nb Nb ivR‰bwZK mfvmgv‡ek, we‡¶vf n‡Z cv‡i| Gi Zxe«ZvI evo‡Z cv‡i| GiB g‡a¨ 10B wW‡m¤^i XvKvi wfbœ GjvKvq i¨vwj ‡NvlYv K‡i‡Q evsjv‡`‡ki eo `yB ivR‰bwZK `j|
G‡Z msNvZ I mwnsmZv e…w× ‡c‡Z cv‡i| d‡j (evsjv‡`‡k Ae¯’vbiZ) gvwK©b bvMwiK‡`i bRi`vwi evwo‡q PjvP‡ji civgk© ‡`qv n‡q‡Q| ejv nq, Avcbvi DwPZ n‡e c«wZev` we‡¶vf Gwo‡q Pjv| ‡Kv‡bv eo mgv‡e‡ki wel‡q mZK©Zv Aej¤^b Ki‡Z n‡e| civgk© ‡`qv n‡q‡Q e¨w³MZ wbivcËv cwiKíbv wiwfD Ki‡Z, Pvicv‡ki wel‡q m‡PZb _ vK‡Z| Gi g‡a¨ Av‡Q ¯’vbxq wewfbœ B‡f›U| civgk© ‡`qv n‡q‡Q cwiewZ©Z cwiw¯’wZi wel‡q ¯’vbxq msev` gva¨g gwbUi Ki‡Z| Aby‡iva Kiv n‡q‡Q me mgq wb‡Ri m‡½ PvR©hy³ ‡gvevBj ‡dvb enb Ki‡Z, hv‡Z Riæwi c«‡qvR‡b ‡hvMv‡hvM Kiv hvq|
‡W¯‹ wi‡cvU©t evsjv‡`‡ki ivRavbx XvKvi bqvcë‡b we‡ivax `j weGbwci ‡K›`«xq Kvh©vjq GjvKvq `jwUi ‡bZv, Kg©x I mg_©K‡`i mv‡_ cywj‡ki e¨vcK msNl© n‡q‡Q| weGbwc `vwe K‡i‡Q msN‡l© cywj‡ki ¸wj‡Z AvnZ n‡q Zv‡`i GKRb Kg©x gviv ‡M‡Q Ges AvnZ n‡q‡Q AviI A‡b‡K| GKB mv‡_ `jwUi hyM¥ gnvmwPe i“ûj Kwei wiRfx mn ‡ek wKQy ‡bZvKg©x‡K `jxq Kvh©vjq ‡_‡K AvUK K‡i‡Q cywjk| bqvcë‡bi GB mo‡KB kwbevi XvKv wefvMxq mgv‡e‡ki ‡Nvlbv w`‡qwQ‡jv weGbwc| hw`I cywjk `jwU‡K XvKvi ‡mvnivIqv`©x D`¨v‡b mgv‡e‡ki AbygwZ w`‡q‡Q| GB mgv‡ek ‡Kv_vq n‡e Zv wb‡q MZ GK mßvn a‡iB ivR‰bwZK A½‡b D‡ËRbv weivR Ki‡Q| weGbwci c¶ ‡_‡K AbygwZ bv wgj‡jI ‡mLv‡b mgv‡e‡ki ‡NvlYv w`‡qwQ‡jb `jwUi ‡bZviv| msN‡l© AvnZ n‡q nvmcvZv‡j ‡bqv GK e¨w³‡K wPwKrmK g…Z ‡NvlYv K‡i‡Qb| cywjk ej‡Q IB e¨w³ Kxfv‡e wbnZ n‡jb ev Zvi ‡Kv‡bv ivR‰bwZK cwiPq Av‡`Š Av‡Q wK-bv ‡m m¤ú‡K© Zviv wbwðZ bb|
DwÏb ‡PŠayix G¨vwb I weGbwci ‡Pqvicvm©‡bi Dc‡`óv cwil‡`i m`m¨ wkgyj wek¦vm‡KI AvUK K‡i cywjk| wg÷vi AvjgMxi `jxq Kvh©vj‡q XyK‡Z bv ‡c‡i evB‡i dyUcv‡Z Ae¯’vb ‡bb| ‡mLv‡bB wZwb mvsevw`K‡`i e‡jb cywjkB nvgjv K‡i‡Q Ges Zviv Avk¼v Ki‡Qb ‡h AviI eo ‡Kvb Pµvš— cywjk Ki‡Q|

ÒAvgv‡K XyK‡ZB ‡`qwU cvwU© Awd‡m| cywjk Awd‡m Xy‡K Avgv‡`i ‡bZvKg©x‡`i AvUK K‡i wb‡q ‡M‡Q| wb‡RivB ‡evgv dywU‡q Zviv wb`©qfv‡e Avgv‡`i Kg©x‡`i Ici nvgjv Pvwj‡q‡Q,Ó ejwQ‡jb wg÷vi AvjgMxi| weGbwc Rvwb‡q‡Q, `‡ji XvKv bMi KwgwUi `yB kxl© ‡bZv, XvKv Dˇii AvnevqK Avgvb Dj vn Avgvb Ges XvKv `w¶‡Yi AvnevqK Avãym mvjvg QvovI `‡ji hyM¥ gnvmwPe Lvqi“j
Kexi ‡LvKb‡KI AvUK K‡i‡Q cywjk| Gw`‡K bqvcë‡b cywjkweGbwc msNl© _vg‡Z bv _vg‡ZB XvKv ‡g‡U«vcwjUb cywj‡ki Kwgkbvi L›`Kvi ‡Mvjvg dvi“K Zvi `dZ‡i msev` m‡¤§jb K‡i e‡j‡Qb, bqvcë‡bi mo‡K mgv‡e‡ki AbygwZ weGbwc cv‡e bv| wZwb ûuwkqvwi ‡`b ‡h, GiKg ‡Kvb ‡Póv weGbwc Ki‡j AvBb Abyhvqx m‡e©v”P K‡Vvi e¨e¯’v ‡b‡eb Zviv|
Kxfv‡e msN‡li« m~Pbv n‡jv NUbv¯’‡j Dcw¯’Z wQ‡jb Ggb K‡qKRb mvsevw`K Rvwb‡q‡Qb 10 wW‡m‡¤^i weGbwci mgv‡ek‡K mvg‡b ‡i‡L MZ wKQyw`b a‡iB `jwUi ‡K›`«xq Kvh©vj‡qi mvg‡b Kg©x mg_©K‡`i wfo evowQ‡jv| AvR eyaeviI mKvj ‡_‡KB mg_©Kiv R‡ov n‡Z ïi“ K‡iwQ‡jb Ges GK ch©v‡q ‡mLvbKvi g~j mo‡Ki `yB cv‡kB hvb PjvPj eÜ n‡q hvq| ‡ejv wZbUvi w`‡K cywj‡ki GKwU `j IB moK ‡_‡K ‡jvKRb‡K m‡i ‡h‡Z e‡j| Gi g‡a¨B GKwU KK‡Uj we‡ùvi‡Yi kã ‡kvbv hvq|
‡¯úvU©m ‡W¯‹t KvZvi wek¦Kv‡c bK AvDU c‡ei« jovB‡q UvB‡e«Kv‡i ‡¯úb‡K 3-0 ‡Mv‡j nvwi‡q ‡KvqvU©vi dvBbvj wbwðZ Ki‡jv gi‡°v| g¨v‡Pi c«_gv‡a© ‡Mvjk~b¨ ‡_‡K weiwZ‡Z hvq gi‡°v I ‡¯úb| g½jevi (6 wW‡m¤^i) evsjv‡`k mgq ivZ 9 Uvq GWy‡Kkb wmwU ‡÷wWqv‡g gv‡V bv‡g GB `yÕ`j| g¨v‡Pi ïiæ ‡_‡KB AvµgY-cvëv Avµg‡Y ‡Lj‡Z _v‡K gi‡°v I ‡¯úb| ‡ek wKQy my‡hvM ‡c‡jI ‡Mvj Ki‡Z e¨_© nq `yÕ`j| ‡kl ch©š— ‡Kvb ‡Mvj bv n‡j ‡Mvjk~b¨ ‡_‡KB weiwZ‡Z hvq ‡¯úb I gi‡°v| Gici weiwZ ‡_‡K wd‡iI ‡Mvj bv n‡j AwZwi³ mg‡q Movq g¨vPwU| AwZwi³ mg‡qI ‡Mv‡ji ‡`Lv bv ‡c‡j ‡kl ch©š— UvB‡e«Kv‡i Movq g¨vPwU| UvB‡e«Kv‡i `yBwU ‡mf w`‡q gi‡°vi R‡qi bvqK Bqvwmb evDby|


AwZwi³ mg‡qi ‡Mv‡ji Avkvq gwiqv n‡q ‡Lj‡Z _v‡K `yÕ`j| g¨v‡Pi 94 wgwb‡U ej wb‡q GwM‡q
‡bIqv kU `vi“Y ‡m‡f `j‡K i¶v K‡ib DbvB wmgb| ‡Mvj
Ki‡Z e¨_© n‡j ‡Mvjk~b¨ ‡_‡K AwZwi³ mg‡qi c«_gva© ‡kl K‡i ‡¯úb I gi‡°v|weiwZ ‡_‡K wd‡i AwZwi³ mg‡qi 106 wgwb‡U Avµg‡Y I‡V ‡¯úb| Z‡e ‡Mvj Ki‡Z e¨_© nq Zviv| Gici AviI wKQy AvµgY K‡i `yÕ`j| Z‡e ‡Mv‡ji ‡`Lv cvq bv ‡KD| g¨v‡Pi
115 wgwb‡U KvD›Uvi A¨vUvK ‡_‡K ‡Mv‡ji my‡hvM ‰Zix Ki‡jI ej Rv‡j Rov‡Z e¨_© nq Iqvwj` ‡PÏvwi| g¨v‡Pi 117 wgwb‡U ej wb‡q GwM‡q hvq ‡gvivZv| ‡Mv‡ji my‡hvM m…wó Ki‡jI ‡Mvj Ki‡Z e¨_© nq ‡¯úb| Gici AviI ‡ek wKQy AvµgY Ki‡jI ‡Mvj Ki‡Z e¨_© nq `yÕ`j|
‡kl ch©š— ‡Mv‡ji ‡`Lv bv ‡c‡j UvB‡e«Kv‡i Movq g¨vPwU|UvB‡e«Kv‡i gi‡°vi c‡¶ c«_g kU wb‡q ‡Mvj K‡ib Av‡ãj nvwg` mvwewi| ‡¯ú‡bi c‡¶ c«_g k‡U ej mvBW ev‡i jvMvb cve‡jv mvevwiqv| Gici gi‡°vi c‡¶ wØZxq kU ‡_‡K ‡Mvj K‡i e¨eavb evovb nvwKg wR‡qm| ‡¯ú‡bi wØZxq kU wb‡Z Av‡mb Kv‡j©v ‡mv‡ji| Zvi kU ‡VwK‡q ‡`b gi‡°vi ‡Mvji¶K Bqvwmb eD‡bv|Gici gi‡°vi c‡¶ Z…Zxq kU wb‡Z Av‡mb evW© ‡e‡bD| Zvi kU ‡VwK‡q ‡`b ‡¯ú‡bi ‡Mvji¶K DbvB wmgb| Z‡e ‡¯ú‡bi Z…Zxq kU wb‡Z Avmv mvwR©I ey‡¯‹‡Ui kUI ‡_wK‡q ‡`b Bqvwmb eD‡bv| Gici gi‡°vi c‡¶ PZy_© kU wb‡Z Avmv Avkivd nvwKwg ‡Mvj K‡i `‡ji Rq wbwðZ K‡ib|‡kl ch©š— UvB‡e«Kv‡i 3-0 ‡Mv‡ji Rq wb‡q gvV Qv‡o gi‡°v| GB R‡q ‡KvqvU©vi dvBbv‡j cv iv‡L gi‡°v| Ab¨w`‡K ‡n‡i wek¦Kvc ‡_‡K we`vq wb‡jv ‡¯úb|
‡¯úvU©m ‡W¯‹t Rvcvb‡K UvB‡eKv‡i 3-1 ‡Mv‡j nvwi‡q ‡KvqvU©vi dvBbvj wbwðZ Ki‡jv ‡µv‡qwkqv| wba©vwiZ mgq ‡k‡l 1-1 ‡Mv‡j mgZvq ‡kl nq Rvcvb-‡µv‡qwkqvi bK AvDU jovB| AwZwi³ 30 wgwbU mg‡qI ‡Mvj Ki‡Z e¨_© nq `yÕ`j| ‡kl ch©š— UvB‡e«Kv‡i Movq g¨vPwU| UvB‡eKv‡i wZb kU AvU‡K w`‡q ‡µv‡qwkqvi R‡qi bvqK nb WwgwbK wjfv‡KvwfP| g¨v‡Pi c«_gv‡a© WvB‡Rb gv‡q`vi ‡Mv‡j GwM‡q ‡_‡K weiwZ‡Z hvq Rvcvb| Z‡e weiwZ ‡_‡K wd‡iB g¨v‡P mgZv Av‡b ‡µv‡qwkqv| g¨v‡Pi 56 wgwb‡U Wvb w`K ‡_‡K µm evovb ‡WRvb jvf‡ib| ‡mLv‡b wW e‡·i ‡fZi ‡_‡K AmvaviY
‡bb Rvcv‡bi wgbvwg‡bv| Zvi kU iæ‡L ‡`b WwgwbK wjfv‡KvwfP| ‡µv‡qwkqvi c‡¶ c«_g k‡U ‡Mvj K‡ib wb‡Kvjv evwmm| Rvcv‡bi wØZxq kU ‡bb KvIiæ wg‡Uvgv| Zvi kUI AvU‡K ‡`b WwgwbK wjfv‡KvwfP| ‡µv‡qwkqv c‡¶ wØZxq k‡U ‡Mvj K‡ib gv‡m©‡jv ‡e«v‡RvwfK| Rvcv‡bi c‡¶ Z…Zxq k‡U ‡Mvj K‡ib ZvKygv Avkv‡bv ‡Mvj K‡ib| ‡µv‡qwkqvi Z…Zxq kU ‡bb gv‡K©v wjfvRv| Zvi kU ‡cv‡÷ ‡j‡M c«wZnZ nq| Rvcv‡bi n‡q gvqvB‡qvwkWvi kUI AvU‡K ‡`b WwgwbK wjfv‡KvwfP| ‡µv‡qwkqvi c‡¶ PZy_© k‡U ‡Mvj

‡¯úvU©m ‡W¯‹t KvZvi wek¦Kvc 2022, A‡b‡Ki g‡ZB ¯§iYKv‡ji me‡P‡q RgRgvU wek¦Kvc, AšÍZ gv‡Vi ‡Ljv ZvB ej‡Q| Rvcvb nvwi‡q w`‡”Q Rvg©vwb‡K, ‡mŠw` Avi‡ei wec‡¶ ‡n‡i hv‡”Q Av‡R©w›Ubv| K¨v‡gi“b ev` covi Av‡M e«vwRj‡K nviv‡bvi myL¯§…wZ wb‡q evwo wd‡i‡Q| Avi gi‡°v GLb ‡KvqvU©vi dvBbv‡j| Kx wQj bv GB wek¦Kv‡c? Avi Kx Kx evwK Av‡Q?
evwK Av‡Q Z…Zxq ¯’v‡bi jovBmn AvUwU g¨vP Avi `kw`‡bi g‡a¨ Rvbv hv‡e wek¦Kvc P¨vw¤úqb `‡ji bvg| GLb mevB ZvwK‡q Av‡Q Kvi nv‡Z DV‡e wek¦Kvc? wek¦e¨vcx A‡bK gvbyl Pvq ‡jvKUv ‡nvK wjI‡bj ‡gwm| A‡b‡K ej‡Qb ‡bBgvi ‡KD ‡KD Pvb K¨vwiqv‡ii ‡kl w`b¸‡jv‡Z ‡ivbvj‡`vi gy‡L nvwm dyUyK|
A‡bK dyUej mg_©K Avevi Pvb bZyb ‡KvbI ‡`k BwZnv‡mi cvZvq bvg ‡jLvK|
A‡b‡K ej‡Qb AveviI Ggev‡c| ‡KvqvU©vi dvBbv‡j gy‡LvgywL Av‡R©w›Ubv ebvg ‡b`vij¨vÛm e«vwRj ebvg ‡µv‡qwkqv Bsj¨vÛ ebvg d«vÝ cZ©yMvj ebvg gi‡°v Av‡R©w›Ubvq ‡gwm Av‡Qb wjI‡bj ‡gwm GL‡bv ch©š— wek¦Kv‡ci ‡miv dyUejvi‡`i GKRb|
e¨w³MZ cvidig¨vÝ wePv‡iI ‡gwmi ‡miv wek¦Kvc hv‡”Q Gevi| Av‡M dvBbvj ‡L‡j‡Qb, ‡Mv‡ìb ejI ‡c‡q‡Qb| wKš‘ Gevi ‡c‡q‡Qb bK AvDU c‡e© ‡Mvj| c«wZevi ‡gwm ej cv‡”Qb, KvZv‡ii ‡÷wWqvg¸‡jv‡Z mevB wmU ‡Q‡o D‡V `vuwo‡q hv‡”Q|
GB eywS ‡Mvj n‡jv, K‡i‡QbI wZbwU B‡Zvg‡a¨| Gi g‡a¨ ‡gw·‡Kvi wec‡¶ `~icvjvi ¯^fvemyjf Ô‡gwm ‡MvjÕ Avi A‡÷«wjqvi wec‡¶ wW‡d݇f`x GK my›`i ‡Mvj ‡h ‡`‡L wewewm ‡iwWI dvBf jvB‡f wiI dvw`©bv›` e‡j‡Qb, ‡gwm Awek¦vm¨| ‡b`vij¨vÛ‡mi wec‡¶ ‡gwm Awek¦vm¨ wKQyB Ki‡eb, Ggb Avkv mg_©K‡`i| Z‡e ‡gwm ev‡`I Av‡R©w›Ubvq Ae`vb ivL‡Qb wjmv‡›`«v gvwU©‡bR| wW‡d‡Ý wZwb ‡`qvj n‡q `vuwo‡q _vK‡Qb| wØZxq ivD‡Û A‡÷«wjqvi wec‡¶ R‡q eo f~wgKv ‡i‡LwQ‡jb ‡Mvji¶K Gwgwjqv‡bv gvwU©‡bR| gvSgv‡V KZ©…Z¡ wb‡q ‡Lj‡Qb iw`«‡Mv wW cj|
wd‡i‡Q bv‡Pi Zv‡j Zv‡j, Zvj wgwj‡q‡Qb ‡KvPI| jyB db nvj ïiæ ‡_‡KB e‡j Avm‡Qb Zvi GB `j wek¦Kvc R‡qi mvg_¨© iv‡L wKš‘ GUv Zv‡`i Rb¨ Pvc bq| KviY `jUv Zi“Y, Zviv hv K‡i‡Q ‡mUvB c«vwßi LvZvq _vK‡e| Avm‡jB ZvB- ‡KvwW M¨vc‡Kv GB wek¦Kv‡c wZb ‡Mvj K‡i‡Qb, Zvi K¬ve wcGmwf AvB›`‡nv‡db GB ÷«vBKv‡ii bv‡gi cv‡k `vg evwo‡q ai‡e Gevi| ‡b`vij¨vÛ‡mi wW‡d‡Ý Av‡Qb wjfvicy‡ji n‡q mdjZv cvIqv fvwR©j db WvBK, gvSgv‡V Av‡Qb d¨vswK wW Bqs| ‡b`vij¨vÛm GB wek¦Kv‡c ‡dfvwiU wn‡m‡e bv G‡jI GL‡bv ch©š— c«vq wbLyuZ ‡L‡j‡Q| KvZvi wek¦Kv‡ci Mªyc c‡e© wZbwU `j ‡KvbI g¨vP nv‡iwbgi‡°v, Bsj¨vÛ I db nv‡ji ‡b`vij¨vÛm| e«vwRj- wdi‡Q mv¤^vi Q›` Mªyc c‡e© e«vwRj wQj ¯^vfvweK, ‡hgb _v‡K e«vwRj `yBUv Rq, GK g¨v‡P nvi, Mªy‡c P¨vw¤úqb| Z‡e wØZxq ivD‡Û D‡VB e«vwRj ‡÷wWqv‡g dyUej ‡L‡jwb ‡Kej, gvby‡li g‡b Avb‡›`i Q›`I wb‡q G‡m‡Q| ‡Mvj K‡i‡Q e«vwRj, D`hvc‡b ‡`wL‡q‡Q e«vwRj ‡Kb mv¤^vi Rb¨ weL¨vZ| wiPvwj©mb, ‡bBgvi, cv‡Kv‡qZv, wfwbwmqvm ‡KD KviI ‡P‡q Kg hvb bv, ‡Mv‡jI, bv‡PI|

`w¶Y ‡Kvwiqv cvËvB cvqwb e«vwR‡ji Kv‡Q| e«vwR‡ji ‡Ljv ‡`‡L mv‡eK ‡Pjwm ÷«vBKvi wµm myUb wewewm‡Z wj‡L‡Qb, Òe«vwRj `w¶Y ‡Kvwiqvi wec‡¶ g¨v‡P Ab¨me `j‡K Rvbvb w`jAvgiv G‡mwQ|Ó ‡bBgvi ‡PvU KvwU‡q wd‡i‡Qb, e«vwR‡ji k³ wW‡dÝ Ges `y`©vš— GK gvSgvV ‡hLv‡b K¨v‡mwg‡iv Av‡Qb, Zviv k³ P¨v‡jÄB Rvbv‡e ‡µv‡qwkqv‡K|
‡µv‡qwkqv- AviI GKevi dvBbv‡ji c‡_? e«vwR‡ji iw`«‡Mv Lywk ‡µv‡qwkqvi mv‡_ ‡KvqvU©vi dvBbv‡ji Rb¨, ‡dmey‡K Rvbvb w`‡q‡Qb ÔjyKv gw`«P, ‡`Lv n‡eÕ|
‡µv‡qwkqv wK ZZUv Lywk n‡Z cvi‡Q?
‡KvP R&jvU‡Kv WvwjP ej‡Qb, Ô‡µv‡qwkqv c«¯—yZ fqsKi e«vwR‡ji wec‡¶ gv‡V bvg‡Z|Õ Wvwj‡Pi `j Rvcv‡bi wec‡¶ UvB‡e«Kv‡i Rq ‡c‡q ‡KvqvU©vi dvBbv‡j wb‡R‡`i RvqMv wbwðZ K‡i‡Q| ivwkqv wek¦Kv‡c ‡µv‡qwkqv bK AvDU c‡ei« wZb g¨vP UvB‡e«Kv‡i wR‡ZB dvBbv‡j RvqMv K‡i wb‡qwQj| ‡mevi d«v‡Ýi Kv‡Q ‡n‡i ivbvi Avc n‡qwQj jyKv gw`«Piv| wddv i¨vswKs‡q ‡µv‡qwkqv we‡k¦i Øv`k `j| WvwjP gvb‡Qb, e«vwRjB ‡dfvwiU| wKš‘ wZwb ej‡Qb, f‡qi ‡KvbI KviY ‡bB| e«vwRj‡K hw` nviv‡Z cv‡i ‡µv‡qwkqv Z‡e ‡mwgdvBbv‡j Zv‡`i c«wZc¶ n‡e, Av‡R©w›Ubv A_ev ‡b`vij¨vÛm|
d«vÝ- AveviI P¨vw¤úqb? AveviI Ggev‡c? Uyb©v‡g›U ïi“i A‡bK Av‡MB wbwðZ cj cMev ‡bB, ‡bB Gb‡Mv‡jv Kv‡š—| Uyb©v‡g›U ïiæ nIqvi GKw`b Av‡M Lei Gj, Kvwig ‡eb‡Rgv ‡Lj‡Z cvi‡eb bv| ‡PvU ‡c‡q‡Qb e¨vjb wW Ai Rqx ZviKv| wKš‘ Gm‡e d«vÝ `‡j ‡KvbI c«fve c‡owb| ‡cvj¨v‡Ûi wec‡¶ mnR Rq w`‡q Zviv ‡KvqvU©vi dvBbv‡j wb‡R‡`i RvqMv cvKv K‡i‡Q| GeviI bvq‡Ki f~wgKvq wKwjqvb Ggev‡c| whwb ‡Mv‡ìb ej I ‡Mv‡ìb eyU `yB RvqMvqB wb‡Ri bvg ivL‡Z cv‡ib| ‡Mvj K‡i‡Qb cvuPwU, wØZxq ivDÛ Awã Uyb©v‡g‡›U m‡e©v”P| ‡Mvj Kiv‡”QbI| Avu‡Zvqv wM«Rgvb Av‡Qb `y`©vš— d‡g©| gvSgvV Zi“Y wKš‘ GL‡bv ch©š— fv‡jv cvidg© K‡i‡Q| me wgwj‡q d«vÝ GeviI ‡dfvwiU wn‡m‡eB ‡Lj‡Q| ‡KvqvU©vi dvBbv‡j d«v‡Ýi c«wZc¶ Bsj¨vÛ| BD‡iv‡ci `yB eo `j GeviB c«_g wek¦Kvc bKAvDU g¨v‡P gy‡LvgywL n‡Z hv‡”Q|
Bsj¨v‡Ûi `yB dyUejvi Bsj¨vÛ- mvD_‡MU mgv‡jvPbvi Reve w`‡”Qb? mgv‡jvPK‡`i A‡b‡KB Bsj¨v‡Ûi g¨v‡bRvi M¨v‡i_ mvD_‡M‡Ui ‡KvwPs-Gi aib cQ›` K‡ib bv| A‡b‡K e‡jb i¶YvZ¥K, A‡b‡K g‡b K‡ib wZwb weP¶Y bb| wKš‘ Zv‡Z Kx? mvD_‡M‡Ui g‡Zv mdj ‡KvP
Bsj¨v‡Û Avi ‡K wQ‡jb? `yB nvRvi AvVv‡iv wek¦Kv‡ci ‡mwgdvBbvj, BD‡ivi dvBbvj ‡L‡j‡Q Bsj¨vÛ mvD_‡M‡Ui Aax‡b| Gev‡ii Bsj¨vÛ AviI ¶yiavi| A‡b‡Ki bRi ‡K‡o‡Qb RyW ‡ewjsnvg| n¨vwi g¨v¸qvi‡K wb‡q cy‡ivcywi wbwðZ wQ‡jb bv A‡b‡K, wKš‘ g¨v¸qvi wb‡R‡K c«gvY K‡i‡Qb| wewewm ‡¯úv‡U© GK Kjv‡g Bsj¨v‡Ûi mv‡eK dyUejvi A¨vjvb wk‡qivi wj‡L‡Qb, ÒAvgvi g‡b nq bv, Bsj¨v‡Ûi f‡qi wKQy Av‡Q|Ó wk‡qivi g‡b K‡ib Bsj¨vÛ wek¦Kvc wR‡Z ‡h‡Z cv‡i, wk‡qiv‡ii g‡Z Bsj¨vÛ Gev‡ii wek¦Kv‡ci fvimvg¨c~Y© `j¸‡jvi GKwU|
gi‡°vi ‡MvjwKcvi Bqvwmb ey‡bv gi‡°v- Uyb©v‡g‡›Ui WvK© nm©? gi‡°v KvZvi wek¦Kvc ‡hfv‡e ‡Lj‡Q Ges gi°vb mg_©Kiv ‡hfv‡e KvZvi gvwZ‡q ‡i‡L‡Qb Zv‡Z g‡bB n‡”Q gi‡°v ‡h Gfv‡e G‡Ki ci GK eo `j‡K civ¯— K‡i ‡KvqvU©vi dvBbv‡j hv‡e, Zv mevB Rvb‡Zb| Avkivd nvwKwg ‡¯ú‡bi wec‡¶ gv‡V bvgvi Av‡MB e‡j‡Qb, PgK AviI ‡`Lv‡Z Pvb Zv iv| nvwKwgi Rb¥ gvw`«‡`, gi‡°vi n‡q ‡L‡jb DBs e¨v‡K|
wZwb AvaywbK dyUe‡ji me‡P‡q Kvh©Ki DBs e¨vK‡`i GKRb| nvwKg wR‡qLI ‡L‡jb gi‡°vi n‡q| Avqv· I ‡Pjwm‡Z ‡Ljv GB ‡c‡gKvi BD‡iv‡c wb‡R‡K c«wZwôZ K‡i‡Qb| ‡¯ú‡bi wec‡¶ gi‡°vi ‡KŠkjB e‡j ‡`q Gev‡ii wek¦Kv‡c
c«wZc‡¶i mKj kw³ I `ye©jZv m¤ú‡K© AeMZ gi‡°v|
‡¯úb 900 Gi ‡ewk cvm w`‡q‡Q wØZxq ivD‡Ûi GB g¨v‡P, gi‡°v w`‡q‡Q 216wU, ‡¯ú‡bi e‡ji ‡cQ‡b ‡Qv‡Uwb gi°vb dyUejviiv|
Zviv A‡c¶v K‡iwQ‡jb, ej G‡j ‡Lj‡eb|
GUv 120 wgwbU Kv‡R w`‡q‡Q, ‡kl ch©š— ‡cbvwë ïUAvD‡U bvqK e‡b ‡M‡Qb gi‡°vi ‡MvjwKcvi Bqvwmb ey‡bv, wZwb ‡¯ú‡bi K¬ve ‡mwfqvi n‡q ‡L‡jb|
‡KvqvU©vi dvBbv‡j gi‡°vi c«wZc¶ cZ©yMvj| cZ©yMvj- ‡ivbvj‡`v‡K ‡e‡Â ewm‡q kw³kvjx n‡jv? wµwðqv‡bv ‡ivbvj‡`vi eqm GLb 37, ‡mB Av‡Mi MwZ, w¶c«Zv, wdwbwks ‡`Lv hvq bv Zvi cv‡q| mv‡_ ‡hvM n‡q‡Q G‡Ki ci GK weZK©, g¨vb‡P÷vi BDbvB‡U‡Wi mv‡_ Pyw³ evwZj, cZ©yMv‡ji ‡KvP dvb©v‡›`v mv‡š— vm‡K Amš‘ó Kiv Ges ‡kl ch©šÍ GKv`‡ki evB‡i hvIqv| we‡k¦i me‡P‡q ‡ewk ‡ckv`vi ‡Mvj Kiv ‡ivbvj‡`v‡K evB‡i ‡i‡LB cZ©yMvj 6 ‡Mvj w`‡q‡QmyBRvij¨v‡Ûi wec‡¶| ‡ivbvj‡`v ‡b‡gwQ‡jb ‡klw`‡K wKš‘ Zv‡Z Zvi mg_©K‡`i g‡bi kvwš— Qvov wKQy cvqwb cZ©yMvj| mgxKiY ‡hgb Av‡Q, dvBbv‡j ‡gwm ebvg ‡ivbvj‡`vI n‡Z cv‡i wKš‘ Zv‡Z Kx Av‡m hvq? ‡ivbvj‡`v ïi“i GKv`‡k Avi my‡hvM cv‡eb? eis ‡ivbvj‡`vi RvqMvq GKv`‡k my‡hvM cvIqv Mbmv‡jv iv‡gvm K‡i‡Qb KvZvi wek¦Kv‡ci c«_g n¨vUwU«K|
‡¯úvU©m ‡W¯‹t dvBbv‡ji Av‡MB dvBbv‡ji ¯^v` ‡`‡e d«vÝ-Bsj¨vÛ g¨vP| `yB civkw³i ‡KvqvU©vi dvBbv‡ji g¨vP wb‡q dyUej‡c«gx‡`i c«Z¨vkv GgbB| Avi wW‡dwÛs P¨vw¤úqb d«v‡Ýi ‡gvKvwejv wb‡R‡`i Rb¨ me‡P‡q eo cix¶v g‡b Ki‡Qb Bswjk ‡KvP M¨v‡i_ mvD_‡MBU|
KvZvi wek¦Kv‡ci Mªycc‡e© ‡Kv‡bv g¨vP nv‡iwb Bsj¨vÛ| Bivb‡K 6-2 ‡Mv‡j nvwi‡q wek¦Kvc ïiæ Kiv Bswjkiv wb‡R‡`i wØZxq g¨v‡P hy³iv‡ó«i m‡½ W« K‡i| Z…Zxq g¨v‡P I‡qjm‡K 3-0 ‡Mv‡j Dwo‡q ‡kl ‡lv‡jvi wUwKU cvq| ivDÛ Ae wm·wU‡b ‡m‡bMvj‡KI GKB e¨eav‡b nvivq w_« jvqbiv| ‡KvqvU©v‡i ‡cŠuQ‡Z ‡Zgb ‡Kv‡bv n¨vwfI‡qU `‡ji ‡gvKvwejv Ki‡Z nqwb GKev‡ii wek¦P¨vw¤úqb‡`i| ‡kl AvU wbwðZ K‡i Bswjk ‡KvP mvD_‡MBU e‡jb, Ô(d«v‡Ýi ‡gvKvwejv) GUv Avgv‡`i
‡¯úvU©m ‡W¯‹t `w¶Y ‡Kvwiqvi wec‡¶ bK-AvDU c‡ei« jovB‡q `w¶Y ‡Kvwiqv‡K 4-1 ‡Mv‡j nvwi‡q ‡KvqvU©vi dvBbvj wbwðZ Ki‡jv e«vwRj| ‡mvgevi (5 wW‡m¤^i) evsjv‡`k mgq w`evMZ ivZ 1 Uvq ‡÷wWqvg 974 G gv‡V bv‡g `yÕ`j| g¨v‡Pi 7 wgwb‡U ‡Mvj K‡i e«vwRj‡K GwM‡q ‡`b wfwbwmqvm Rywbqi| Gici ‡bBgvi, wiPvwj©mb I jyKvm cvKy‡qZv ‡Mvj Ki‡j Pvi ‡Mv‡j GwM‡q ‡_‡K weiwZ‡Z hvq e«vwRj| weiwZ ‡_‡K GK ‡Mvj ‡kva K‡i `w¶Y ‡Kvwiqv| Gici Avi ‡Kvb ‡Mvj bv n‡j 4-1 ‡Mv‡ji Rq wb‡q gvV Qv‡o ‡m‡jmvIiv| g¨v‡Pi ïiæ ‡_‡KB j¤^v cv‡m AvµgY Kivi ‡Póv K‡i e«vwRj| c«_g A¨vUvK ‡_‡KB ‡Mv‡ji ‡`Lv cvq e«vwRj| g¨v‡Pi 7 wgwb‡U evg w`K ‡_‡K mvRv‡bv Avµg‡Y I‡V e«vwRj| evg w`K ‡_‡K ivwdbnvi evov‡bv ej cvq wW e‡·i dvuKvq `vwo‡q _vKv wfwbwmqvm Rywbqi| VvÛv gv_vq AmvaviY k‡U ej Rv‡j Rovb wZwb| Zvi ‡Mv‡j g¨v‡Pi ïi“‡ZB wjW cvq e«vwRj| g¨v‡P GwM‡q wM‡q AviI Avµg‡Y avi evovq e«vwRj| g¨v‡Pi 11 wgwb‡U e‡·i ‡fZ‡i wiPvwj©mb‡K dvDj Ki‡j ‡cbvwë cvq e«vwRj| ‡cbvwë ‡_‡K ‡Mvj K‡i e«vwRj‡K `yB ‡Mv‡ji wjW G‡b ‡`b BbRywi KvwU‡q `‡j ‡div ‡bBgvi| VvÛvi gvVvq AmvaviY k‡U
me‡P‡q KwVb cix¶v|Õ


‡cvj¨vÛ‡K 3-1 ‡Mv‡j weaŸ¯— K‡i ‡KvqvU©vi dvBbv‡ji wUwKU
‡K‡U‡Q d«vÝ| wW‡dwÛs P¨vw¤úqbiv ‡h Q‡›` i‡q‡Q Zv‡Z mvD_‡MB‡Ui fq cvIqv Ag~jK bq| wZwb e‡jb, ÔZviv wek¦P¨vw¤úqb `j|
‡gavex ‡L‡jvqv‡o fiv Zv‡`i ‡¯‹vqvW|
eo P¨v‡j‡Äi ‡gvKvwejvi c«¯—ywZ wb‡Z n‡e|Õ KvZvi wek¦Kv‡c B‡Zvg‡a¨B 5 ‡Mvj K‡i‡Qb wKwjqvb Ggev‡à| 2018 Avm‡i K‡iwQ‡jb 4 ‡Mvj| 23 eQi eqmx Ggev‡à‡K wb‡q mvD_‡MBU e‡jb, Ôwek¦gv‡bi ‡L‡jvqvo Ggev‡à| PjwZ Ges Av‡Mi wek¦Kv‡c `viæY cvidig¨vÝ ‡`wL‡q‡Q ‡m|Õ
Au‡Zvqvb wM«Rg¨vb Ges Awjwf‡qi wRiæi c«ksmvI K‡i‡Qb Bsj¨vÛ ‡KvP| mvD_‡MBU e‡jb, ÔwM«Rg¨vb d«v‡Ýi Rvwm©‡Z Uvbv 70wU g¨vP ‡Lj‡Qb| ‡m AmvaviY GKRb ‡L‡jvqvo| Awjwf‡qi wRiæI `y`©vš—| Zv‡`i Awek¦vm¨ me ZiæY wgWwdìvi i‡q‡Q| d«vÝ `j wb‡q ÷vwW Ki‡j Avcwb ‡`L‡Z cv‡eb, Zv‡`i c«‡Z¨K cwRk‡b ZviKvq fiv|Õ
g¨v‡Pi 26 wgwb‡U gvSgvV ‡_‡K ej wb‡q wW e‡· Xy‡K hvq ‡bBgvi| Z‡e Kb©v‡ii wewbg‡q wK¬qvi K‡i ‡`b `w¶Y ‡Kvwiqvi wW‡dÛviiv|
g¨v‡Pi 28 wgwb‡U Kb©vi cvq e«vwRj| Kb©vi ‡_‡K wdiwZ e‡j mvRv‡bv AvµgY ‡_‡K w_qv‡Mv wmjfvi cvm ‡_‡K ej ‡c‡q Rv‡j Rovb wiPvwj©mb| g¨v‡Pi 29 wgwb‡U ‡Mvj K‡ib wZwb| Zvi ‡Mv‡j wZb ‡Mv‡ji wjW cvq e«vwRj| Gici g¨v‡Pi 32 wgwb‡U Avµg‡Y hvq `w¶Y ‡Kvwiqv| evg w`K ‡_‡K ej wb‡q wW e‡· Xy‡K kU K‡ib
K‡ib
wnDs wgb mb| Z‡e AviI GKevi AmvaviY ‡m‡f wb‡R‡`i Rvj A¶Z iv‡Lb A¨vwjmb ‡eKvi| g¨v‡Pi
eo f~wgKv ‡i‡L hviv c«wZc‡¶i Rv‡j ej Rwo‡q‡Qb GKvwaKevi, ZvivB GLb GwM‡q i‡q‡Qb wek¦Kv‡ci me©”P ‡Mvj`vZvi cyi¯‹vi ‡Mv‡ìb eyU ‡RZvi jovB‡q|
5 ‡Mvj wb‡q GB gyû‡Z© ‡Mv‡ìb ey‡Ui jovB‡q kx‡l© i‡q‡Qb d«v‡Ýi wKwjqvb Ggev‡à| Avevi 3 ‡Mvj _vKv wjI‡bj ‡gwm, wiPvwj©mb, eyKv‡qv mvKv ev Awjwf‡qi wRiæ`‡`i mvg‡bI my‡hvM Av‡Q ‡Mv‡ìb ey‡Ui jovB‡q mevi Dc‡i D‡V hvIqv|
AvMvgx ïµevi (9 wW‡m¤^i) ‡_‡K ïiæ n‡e KvZvi wek¦Kv‡ci ‡KvqvU©vi dvBbv‡ji jovB| Zvi Av‡M Pjyb GK bR‡i ‡`‡L ‡bIqv hvK ‡KvqvU©v‡ii Av‡M ‡Mv‡ìb ey‡Ui jovB‡q GwM‡q i‡q‡Q ‡Kvb ZviKviv‡Mvj`vZv ‡Mvj msL¨v
‡¯úvU©m ‡W¯‹t gi“i ey‡K c«_g wek¦Kv‡ci c«_g ce© ‡cwi‡q ‡kl n‡q ‡M‡jv bKAvDU ivDÛI| KvZv‡ii gvwU‡Z 32 `‡ji jovB GLb 8 `‡ji| wek¦Kv‡ci ‡mvbvi U«wd Kvi nv‡Z DV‡Q Zv ‡`L‡Z Avi gvÎ 7 g¨v‡Pi A‡c¶v| wØZxq ce© ‡k‡l ‡KvqvU©v‡ii wUwKU
wbwðZ K‡i‡Q e«vwRj, Av‡R©w›Ubv, d«vÝ, Bsj¨v‡Ûi g‡Zv nU ‡dfvwiU `j¸‡jv| Avevi Zv‡`i m½x n‡q PgK ‡`Lv‡bv gi‡°vI i‡q‡Q ‡kl Av‡Ui jovB‡q| ‡¯ú‡bi g‡Zv wk‡ivcv c«Z¨vkx `j S‡i c‡o‡Q bK-AvDU ‡_‡KB| c«_g c‡e© PgK ‡`wL‡q bK-AvD‡U Avm‡jI eo g‡Â Avi wb‡R‡`i
‡g‡j ai‡Z cv‡iwb `w¶Y ‡Kvwiqv, Rvcvb ev ‡m‡bMv‡ji g‡Zv `j¸‡jv|
‡KvqvU©vi dvBbv‡ji jovB ïiæi Av‡M i‡q‡Q `yBw`‡bi weiwZ| wRZ‡j wk‡ivcv w`‡K AviI GKavc GwM‡q hvIqv, nvi‡j ai‡Z n‡e evwoi c_| `j¸‡jvi nvÇvnvwÇ
jovB‡qi gv‡S dyUejvi‡`i g‡a¨I ïiæ n‡q ‡M‡Q e¨w³MZ ‡Mv‡ìb ey‡Ui jovB| c«_g ce© ‡k‡l bK-AvDU ‡cwi‡q ‡KvqvU©v‡i IVvi jovB‡q R¡‡j D‡V‡Qb A‡bK ZviKv, A‡bK `j Avevi `jxq cvidig¨v‡ÝB ‡cŠu‡Q‡Qb ‡KvqvU©v‡i| `‡ji R‡q
wKwjqvb Ggev‡à (d«vÝ)5 ‡Mvj wjI‡bj ‡gwm (Av‡R©w›Ubv)3 ‡Mvj wiPvwj©mb (e«vwRj) 3 ‡Mvj Awjwf‡qi wRiæ` (d«vÝ)3 ‡Mvj ‡KvwW M¨vK‡cv 3 ‡Mvj eyKv‡qv mvKv 3 ‡Mvj MÄv‡jv iv‡gvm 3 ‡Mvj
‡cŠu‡Q ‡Mj cZ©yMvj| bKAvDU c‡ei« ‡kl ‡Ljvq myBm‡`i 6-1 ‡Mv‡j nvwi‡q‡Q ‡ivbvj‡Wviv| hw`I g¨v‡Pi c«_gv‡a© GKv`‡k ‡`Lv hvqwb `‡ji ZviKv ‡cqvi ‡ivbvj‡Wv‡K| Zvi e`‡j c«_g GKv`‡k bvgv 21 eQi eqmx MÝv‡jv iv‡gv‡mi n¨vwU«K I ‡c‡c, ivdv‡qj ¸‡q‡i‡iv Ges ivdv‡qj ‡j‡qvi Kiv ‡Mv‡j 16 eQi ci AveviI ‡KvqvU©vi dvBbv‡j DV‡jv cZ©yMvj| ‡kl 2006 mv‡ji wek¦Kv‡c ‡KvqvU©vi dvBbv‡j ‡Ljvi my‡hvM ‡c‡qwQj `jwU|evsjv‡`k mgq ivZ 1Uvq jymvBj AvBKwbK ‡÷wWqv‡g myBm‡`i wec‡¶ gv‡V bv‡g cZ©yMvj| g¨v‡Pi 17 wgwb‡UB c«_g ‡Mvj cvq cZ©yMvj| evg cvk ‡_‡K ‡nvqvI ‡dwj‡·i cv‡m ‡Mvji¶‡Ki gv_vi Dci w`‡q MÝv‡jv iv‡gv‡mi ‡KvbvKywb k‡U c«_g ‡Mv‡ji ‡`Lv cvq cZ©ywMRiv| g¨v‡Pi 33 wgwb‡U 2q ‡Mv‡ji DZm‡e gv‡Z cZ©yMvj| Gevi Kb©vi ‡_‡K `vi“Y ‡n‡W ‡Mvj K‡ib 39 eQi eqmx wW‡dÛvi

wgwb‡U g¨vby‡qj AvKvwÄ myBm‡`i n‡q GKwU ‡Mvj ‡kva ‡`b| Z‡e ‡mB Avb›` ‡ewk¶Y ¯’vqx nqwb| 67 wgwb‡U cZ©yMv‡ji n‡q wb‡Ri Z…Zxq I `‡ji 5g ‡MvjwU K‡i

K‡iwQ|Õ e‡jb mvdv| mvdv GKmgq wkíx‡`i Kv‡Q wb‡Ri
AvuK‡Z w`‡Zb, ‡mUv wQj `xN© mgqmv‡c¶| wKš‘ GLb c«hyw³ A‡bK ‡ewk GwM‡q‡Q| ÔQwe¸‡jv f³‡`i m‡½ fvMvfvwM Kivi Kvi‡Y wb‡R‡K Ab¨fv‡e ‡`Ljvg|Õ e‡jb mvdv| mvdv GKmgq wkíx‡`i Kv‡Q wb‡Ri Qwe AvuK‡Z w`‡Zb, ‡mUv wQj `xN© mgqmv‡c¶| wKš‘ GLb c«hyw³ A‡bK ‡ewk GwM‡q‡Q| ÔQwe¸‡jv f³‡`i m‡½ fvMvfvwM Kivi Kvi‡Y wb‡R‡K Ab¨fv‡e ‡`Ljvg|Õ e‡jb mvdv| mvdv g‡b K‡ib, c«hyw³ A‡bK GwM‡q‡Q| ïay Qwe bq, Rxebhvc‡bi A‡bK eo welq i‡q‡Q ‡mLv‡bI c«hyw³i Af¨¯— Zv Ri“wi| wZwb e‡jb, Rxeb mnR I wbivc` Kivi Rb¨ n‡jI

mevB‡K c«hyw³i m‡½ Zvj wgwj‡q Pjv DwPZ| G‡Z mgq ‡hgb evuP‡e, ‡Zgwb bvix‡`i A‡bK c«wZK~j cwi‡e‡ki g‡a¨ co‡Z n‡e bv| mvdv g‡b K‡ib, c«hyw³ A‡bK GwM‡q‡Q| ïay Qwe bq, Rxebhvc‡bi A‡bK eo welq i‡q‡Q ‡mLv‡bI c«hyw³i Af¨¯—


Zv Ri“wi| wZwb e‡jb, Rxeb mnR I wbivc` Kivi Rb¨ n‡jI mevB‡K c«hyw³i m‡½ Zvj wgwj‡q Pjv DwPZ| G‡Z mgq ‡hgb evuP‡e, ‡Zgwb bvix‡`i A‡bK c«wZK~j cwi‡e‡ki g‡a¨ co‡Z n‡e bv| Ô@ 18-Aj UvBg ‡`Š‡oi IciÕ— bvUK w`‡q Awfb‡q c«ksmv cvb mvdv| ‡mB ‡_‡K GL‡bv wZwb wbqwgZ Awfbq K‡i hv‡”Qb| Awfbq wb‡qB _vK‡Z Pvb| Ô@ 18-Aj UvBg ‡`Š‡oi IciÕ— bvUK w`‡q Awfb‡q c«ksmv cvb mvdv| ‡mB ‡_‡K GL‡bv wZwb wbqwgZ Awfbq K‡i hv‡”Qb| Awfbq wb‡qB _vK‡Z Pvb|

Bangla Sanglap Desk: Some royals questioned why Meghan should be protected from press harassment, Prince Harry has claimed in the couple's new Netflix documentary.
Harry said some members of the family felt negative treatment in the media was "a rite of passage" - but he added: "The difference is the race element."
The first three episodes of the six-part bombshell series, titled Harry & Meghan, were released on Thursday.
The couple talk about life in the Royal Family, press intrusion and racism.
Buckingham Palace has not yet responded to the claims.
At the start of episode one, a message says members of the Royal Family declined to comment on "the content within this series".
But Buckingham Palace and Kensington Palace say that neither they, nor any other members of the Royal Family, had been
approached for comment.
The episodes released on Thursday - which include sit-down interviews with the couple and their friends, as well as a video diary - cover a range of topics, including the couple's difficult relationship with the tabloid press, and the Royal Family's response to racist news articles written about Meghan.
"The direction from the Palace was don't say
anything," says Harry. "But what people need to understand is, as far as a lot of the family were concerned, everything that she was being put through, they had been put through as well.

"So it was almost like a rite of passage, and some of the members of the family were like 'my wife had to go through that, so why should your girlfriend be treated any differently? Why should you
get special treatment? Why should she be protected?"'
"I said 'the difference here is the race element'."
He says there is a "huge level of unconscious bias" in the Royal Family, adding: "It is actually no one's fault. But once it has been pointed out, or identified within yourself you then need to make it right." The Duke of Sussex - who is fifth in line to the throne - says he is really
proud that his children are mixed race, and it makes him want to "make the world a better place for them".
"But, equally, what's most important for the two of us is to make sure that we don't repeat the same mistakes that perhaps our parents made."
The couple also spoke about meeting other royals, with Meghan saying she found it surprising that the formality "carries over" even when not in public.
She says: "When Will and Kate came over, and I met her for the first time, they came over for dinner, I remember I was in ripped jeans and I was barefoot. I was a hugger. I've always been a hugger, I didn't realise that that is really jarring for a lot of Brits.
"I guess I started to understand very quickly that the formality on the outside carried through on the inside."
The NHS, DHSC (Department of Health and Social Care) and UKHSA (UK Health Security Agency) are working with local communities to share the importance of protecting ourselves this winter. Multilingual street champions will be located in the streets of London over the next few weeks to give free advice and information about COVID-19 and flu vaccinations.
The winter street teams are inviting people in the community with questions about vaccinations and how they work to come and speak to them. During colder weather, viruses circulate more and cause greater harm. Catching COVID-19 or flu for most people is unpleasant, but for some can be very dangerous. If you get both at the same time, the chance of being very unwell or going into hospital is even greater.
Getting your vaccines when invited gives you and your loved ones the best protection
from serious illness and hospitalisation. COVID-19 vaccines can be booked online

at www.nhs.uk/get-vaccination, calling 119 for free, or in some areas you can find a local
vaccination walk-in centre. To find out more about the flu vaccine and who is eligible
including children, visit www. nhs.uk/flujab
Street teams will be available at the following locations over the coming weeks:
Friday 2nd December
Poplar, Shadwell North Bengali, Sylheti, Somali, Urdu, Hindi, Gujarati, Punjabi, Polish speakers
Friday 2nd December Forest Gate, Green Street, East Ham Urdu, Punjabi, Hindi speakers
Saturday 3rd December
Haringey, Wood Green Polish, Romanian, Urdu, Punjabi, Hindi, Tamil, Gujarati speakers
Saturday 3rd December Well Street. Hackney Central, Lower Clapton Urdu, Punjabi, Hindi speakers
Sunday 4th December Forest Hill Area, Catford Broadway Twi, Yoruba, Urdu, Punjabi, Hindi, Tamil, Bengali speakers
Friday 9th December
Kilburn High Road Urdu, Punjabi, Hindi speakers
Pregnant women are eligible for both a free flu and Covid-19 booster vaccine this winter. Pregnancy can be an exciting, yet vulnerable time for any woman, but Covid-19 fears and isolation have added an extra strain. It feels like it is all behind us now, but viruses like Covid-19 and flu can spread more easily in winter when we all mix more indoors, so healthcare experts are advising expectant mums to make sure they get their vaccines.
Over a million babies were born in the UK during the height of the pandemic. We talked to three mums about their decisions on vaccination and experiences of having a baby in the pandemic.
“I was lucky enough to have my baby in the latter part of the pandemic,” says Paediatrician and mum of three Dr Kiran Rahim, “Lots of things felt weird and strange at a time of happiness, like my husband not being allowed in for a scan. Many services like dropin weight clinics and breastfeeding support were cancelled due to Covid restrictions. The worst part was the lack of contact with health visitors.”
“I had my two Covid vaccines and then a booster and a flu jab while pregnant”, says Dr Rahim. “And as a frontline healthcare worker, I am eligible for Covid-19 booster and flu jab this winterwhich I have just had, whilst still breastfeeding. Both immunisations are safe at any stage of pregnancy, and many millions of doses have been administered worldwide to pregnant women.”

While the vaccines are safe, there are risks from both viruses during pregnancy.
be very dangerous for both mother and baby. In the very worst cases, they can lead to death or stillbirth,” says Dr Rahim. “There are new variants of Covid all the time, it’s unpredictable and the risks are still out there. The flu virus can also change each year, so it’s important to boost your protection to both viruses before winter.”
“This is not the time
to be complacent,” says Dr Rahim.Falling ill presents additional risks while pregnant. Vaccines are our best line of defence, which are freely available on the NHS and easy to get.
Unfortunately, trainee clinical scientist Tanviha Quaraishi-Akhtar experienced some of these complications first-hand. Tanviha had an emergency C-section after falling seriously ill with Covid,
giving birth at just 33 weeks. She was so unwell with Covid that she couldn’t hold her premature son before he was rushed to the neonatal intensive care unit.
“Just a week later, I was in ICU alone, in a medically induced coma. I almost died and was kept unconscious for over two months. I finally met and held my son when he was 12 weeks old. It is so sad to think I missed out on these important

early months. Had the vaccine been available whilst I was pregnant, I would have definitely accepted it, and my experience could have been avoided”.
As a scientist, Tanviha believes it’s so important for people in the Asian community to make sure they get their information about vaccines from a reliable source like the NHS website –there’s far too much misinformation out there and you shouldn’t trust everything you read on social media.
“I got the Covid vaccine while pregnant last year, and I’d do it again,” says influencer and blogger Samira Ahmed. “I was really sick with the Delta variant in my first trimester and was lethargic for months after recovering. I was so worried that getting sick had harmed my baby. I wanted to avoid catching it again and got vaccinated - it was a load off my mind.”
Samira also makes sure her four-year-old gets the flu vaccine as a nasal spray. “I don’t want him to miss out on school and vaccines make these things avoidable.”I also had him vaccinated each autumn when he was a pre-schooler.
A UK study found that pregnant women admitted to hospital with Covid infection having received 2 or 3 vaccine doses, were less likely to have more severe disease or require intensive care admission than women who had not been vaccinated. However, uptake of vaccines is lower in Asian communities –last winter for example, just 29% of Pakistani pregnant women had the flu jab.
Studies show that protection provided by Covid-19 vaccines decreases over time, even if you’ve had previous doses of the vaccine.So, it’s important you ‘top up’ your immunity this autumn. Pregnancy alters how the body handles infections such as flu, which is why you are advised to get the flu vaccine too. It’s safe to get both vaccines together. They do not contain live viruses and cannot infect the baby.
Find out how to book your vaccine appointments now at your GP surgery, local pharmacy or check with your maternity service. Visit nhs.uk/ wintervaccinations
“Complicationsfrom Covid and flu while pregnant can





